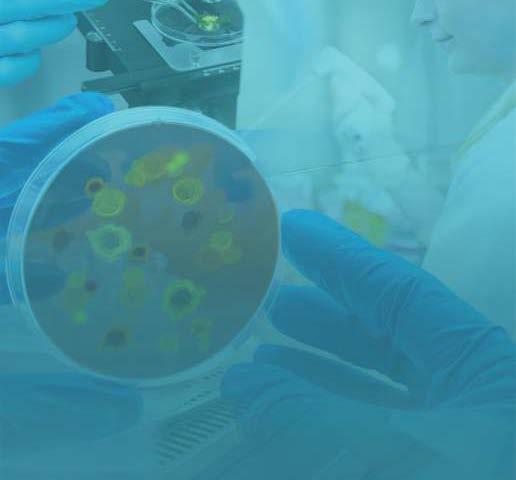

La felicidad y bienestar
10 l rol e la e er er a o ol i a 14 C o re ararse a es e visi ar el la ora orio l i o 18 eva e olo a ara el ia s i o e o las a e o ia 20 a vi a i a o la vi a i a el sol 24 ie os i iles ara la e ele ia 28 er ere ia e io i a e r e as e la ora orio 30 el Covi al ro la re ara i es lave 34 revis a e or a a 41 le e o s e ial a ora orios e ele ia 140 a ro o i o e ia s a sa 142 l la iroi es a ari osa e o rola er o 144 C er e la iel e e os sa er o reve irlo 148 s ie ia ar a a o allo ar a o 150 l e lo o i o e la so ie a s rol i or a ia re os 152 Co o e so re los so los el ora o o e e arlos e los i os 158 a ri era e ora a si l ea e e a Covi 162 a e vis al a al o o a era reve iva ara a e er a ali a vis al er e a 164 la es e se o o e e es sa er 167 l i a o e la iel a i es sal 170 e i i a e el la ora orio 172 Cele ra i alavi a rese a i elli ro ela ra Cesia s e a e 174 re i e a re i a i C 178 ris o i o i a ro esio al ries os














Conmásdecuarenta añosdeexperiencia sirviendoanuestros pacientes,contamoscon ungrupodetrabajo altamenteentrenadoy cualificadoparabrindarel mejorservicioalpúblico.












Damosanuestros visitantesuntratoamable yamistosoquenos dis�nguedelosdemás.


Mencionar los diferentes roles de la enfermería Oncológica requiere abarcar diferentes enfrentamientos
en el día a día con la vida y con la muerte de pacientes que sufren la amenaza de una de las bendiciones más preciadas del ser humano la salud con un diagnóstico de cáncer.
Asumimos un rol integral y especializado, utilizamos estándares más abarcadores que en otras ramas de la enfermería, porque no sólo se limita a necesidades fisiológicas médicas o su gestión a un tratamiento.
Va más allá, éste va dirigido a ofrecer un plan estratégico humanizado, cálido y seguro basado en una intervención con un sentido holístico que permite la atención al paciente de forma que cubra todas las necesidades básicas que incluya a toda la familia. Nuestra tarea es ardua junto al equipo Multidisciplinario de salud. Ofrecemos herramientas para lograr detener la enfermedad con éxito.
recuperación del paciente recalcando siempre su cooperación que debe ir de la mano con su deseo de vivir Identificamos necesidades psicológicas espirituales y exhortamos acercamiento con Dios el ser superior para que pidan la sanación y curación
Para garantizar la calidad de servicios asumimos un rol investigativo de terapias de tratamiento junto con el médico que mejoren la práctica cuando se trata de gestiones y servicios para actuar con rapidez.
Cuando hablamos de relación enfermera a paciente la empatía es la clave y el sentido a la vocación por lo que hacemos debe prevalecer.
Por ello, la intervención y planificación de tratamientos están centradas en proporcionar información para que el paciente se adapte a los cambios físicos y a su estilo de vida después del diagnóstico de cáncer, nuestra meta es lograr que el paciente pueda vencer la enfermedad enfrentar sus miedos y pueda integrarse a la sociedad sin perder su independencia. Observamos al paciente oncológico como un ser biopsicosocial, un ser que está en constante cambio e interacción con su entorno. El rol de la enfermera Oncóloga requiere destrezas avanzadas, juicio clínico, capacidad de análisis, amor y tolerancia; conlleva priorizar tratamientos de quimioterapias, manejo de medicamentos efectos adversos; ofrecemos guía de nutrición; estrategias de autocuidado y también establecemos formas de integrar a la familia que ayuden en los cuidados básicos de el paciente.
Las habilidades de comunicación entre la familia deben permanecer presentes durante todo el tratamiento.
Nuestro rol integral basado en nuestra función clínica será la clave para la
Cuando hablamos de relación enfermera a paciente la empatía es la clave y el sentido a la vocación por lo que hacemos debe prevalecer sabemos que cada paciente es único y se debe trabajar individualmente En lo emocional estamos frente a retos e historias que marcan nuestras vidas y dejan huellas imborrables vemos reflejados a una madre o padre igual a nuestra familia luchando por sobrevivir. Requiere control de emociones que ponen en juicio lo que hacemos.
Vemos familias quebrantadas y pedir que los ayuden a aceptar que su ser querido esté en su etapa final es ahí donde las ejecutorias se agotan y la frustración nos invade y debemos decirnos
“yo estuve aporté mis conocimientos, mi paciencia y amor, pero Dios decide, solo fui un instrumento para acompañarte y prepararte ”
El Rol de la Enfermería Oncóloga es un arte más allá de la ciencia. Trabajamos para que un área de tratamiento sea un comienzo de una calidad de vida, no un final. Conlleva sacrificios, desafíos que deprimen y cambian nuestra forma de ver la vida! Significa tolerancia, amor por lo que hacemos, ése es nuestro rol.








Prueba para Industria de limento Prueba de Plomo para los i os eadstart Prueba para Matrimonio Prueba de emoglobina Prueba para scuelas y niversidades



Pruebas para Cer� cado de Salud Prueba de Dopa e Prueba de Influenza y otros
a Cer� cado de Salud fluenza
Una prueba de laboratorio es un procedimiento en el que un profesional de la salud, usualmente una enfermera, toma una muestra de sangre o le instruye tomar muestras de orina, excretas u otras pruebas especiales. El análisis de estas brinda al médico información importante para diagnosticar enfermedades, vigilar un tratamiento o monitorear alguna condición.

Sin embargo, para muchos pacientes visitar el laboratorio clínico puede ser estresante. A continuación, le indicamos algunas recomendaciones para ayudarlo a usted a sentir menos ansiedad.
Ÿ
Puedeingerirtodaelaguaquedeseemientrasestádeayunas.Si estáhidratado,puedeayudaraencontrarlasvenasmásrápido.
Ÿ
Normalmenteserecomiendaunayunomínimode8a10horas.Si realmentenoestáenayunas,comuníquelo.
Ÿ
Trate de estar lo más relajado posible. Vista ropa que le permita exponercómodamentelosbrazosparalaextraccióndesangre.
ŸSitiene“venasdifíciles”,comuníquelo.
Ÿ
Sitienetendenciaamarearse,debeavisarantesdelaextracción ydebeveniracompañado.
ŸNodebehacerejerciciosnifumarantesdellegarallaboratorio.
Ÿ
Mantenga su rutina normal de alimentación a menos que su médicoleindiquelocontrario.
Ÿ
Debenoticarsitomóalgúnmedicamento.
Ÿ
Debe seguir al pie de la letra las instrucciones del laboratorio en casosdemuestrasquerequieraninstruccionesespeciales.
Cómo preparar a su hijo
Ÿ
A continuación, algunas medidas para que los padres puedan ayudarasushijosalmomentodevisitarellaboratorioclínico.
ŸSería recomendable explicarle al niño por qué necesita la prueba y cómo se le tomarán las muestras. Use palabras que el niño
pueda entender según su edad. Asegúrele que usted va a estar conéltodoeltiempo.
ŸDebeserfranco.Silapruebapuedecausardolor,noledigaalniño que no le va a doler. Dígale que podría causar un poco de dolor, peroqueeldolordesaparecerápronto.
ŸNo lo engañe diciéndole que la prueba no es para él. Muchas veceslosniñosmuestrancorajeporhabersidoengañadosyesto hacemásdifícillatomadelamuestra.
Ÿ
Podría practicar hacer respiración profunda y pensar en cosas alegres o contar lentamente del uno al diez antes de llegar al laboratorio.
Ÿ
Si el niño necesita una prueba que requiere estar en ayunas, puede llevar un refrigerio para después de la prueba u ofrecerle llevarloadesayunardondemásleguste.
Ÿ
Ofrézcaletomarbastanteagua,mientrasmáshidratadomejor.
Ÿ
Podríallevarsujuguetefavoritoounjuegoparadistraerloantesy durantelaprueba.
Ÿ
Puedemostrarsuapoyofísicotomándolelamanoalniñodurante la prueba. Si su hijo es un bebé, háblele con un tono de voz calmadoytranquilo.
Ÿ
Muchasvecesofrecerunarecompensapuedeservirparadistraer alniñoyfomentarlacooperaciónduranteelprocedimiento.
La obtención de la muestra es la primera condición que puede afectar un análisis de calidad. No podemos obtener un resultado confiable partiendo de una muestra que no llena los requisitos necesarios para su análisis. Por eso es tan importante que los pacientes sigan las recomendaciones y puedan contribuir a un resultado confiable. Esto ayudará el médico a un mejor diagnóstico, tratamiento y seguimiento de la condición de sus pacientes.





Servicios:




Aceptamos la mayor a de los planes médicos. Ser icio omicilio Ser icio a mpresas Lab press esultados por internet ápido y Se uro. Lab raph na rá ca para e aluar el historial de la salud con una sola mirada. Pruebas de Pre ención speciali adas Pruebas de Pre ención e ulares

Horarios
L-V: 6:00am- :00pm S: :00am-1:00pm
Calidad y celencia a tra és de las eneraciones. ilson ópez y su ija ara ópez









La mycoplasma pneumoniae es una bacteria causante de algunas infecciones pulmonares, incluyendo casos leves de neumonía también conocida como neumonía errante o atípica . Lasinfeccionespormycoplasmapueden ocurrirencualquiermomentodelaño, aunque son más comunes a finales del verano y en otoño.
Elmycoplasmasetransmiteatravésdel contacto con partículas cuando una persona infectada tose o estornuda y por contacto con secrecionesnasalesydelagargantade personas infectadas.
Losbrotesdeestabacteriaocurren principalmenteenentornosconcurridos comoescuelas,hospedajes,hogaresde ancianos y hospitales.
Los síntomas suelen aparecer después de a semanas del contagio y dependen del tipo de infección, aunque en su gran mayoría son leves. El tipo más común de infección es la traqueobronquitis resfriado en el pecho , peropuedeocurrirneumonía infección pulmonar . La neumonía suele ser leve y raramenterequierehospitalización.Los síntomas pueden persistir desde algunos días hasta más de un mes.
Los síntomas más comunes incluyen: Ÿ olor de ar anta ŸSensación de cansancio Ÿ os con recuencia seca Ÿ olor de cabe a Ÿ iebre y escalo r os
i cultad para respirar
olor de pecho
ambién se pueden presentar in ecciones del o do medio otitis media
Ante una complicación grave la persona puede presentar: Ÿ eumon a ra e
Asma
nce alitis in amación del cerebro
Anemia hemol tica
Problemas renales
rastornosdelapielcomos ndromede Ste ens-Johnson eritemamulti orme necrólisis epidérmica tó ica
¿Existe tratamiento?
Existen varios tipos de antibióticos para tratar unainfeccióncausadapormycoplasma pneumoniae.Muchaspersonasllegana recuperarse sin necesidad de antibióticos. Consulteconsumédicopararecibirun tratamiento adecuado para usted.
Pueden ocurrir segundas infecciones Aunque se produce una inmunidad después de una infección por mycoplasma, esta no es duraderaysuelenocurrirsegundas infecciones, que pueden ser más leves.
Para prevenir la propagación y contagio son importantes las buenas prácticas de higiene: ŸC brase la boca y la nari con un pa uelo cuando tosa o estornude. C brase con un pa uelo con la parte superior de la man a o el codo no en las manos.
Ÿ escarte el pa uelo en el a acón lue o de utili arlo.
ŸLá ese las manos con recuencia con a ua y abón durante al menos 20 se undos.
ŸSinohaya uay abón disponibles useun desin ectante para manos a base de alcohol.
Ÿ tilice mascarilla.
ŸSi está en ermo e ite contacto con otras personas.
Pruebas de laboratorio Existen pruebas de laboratorio
no específicas para su diagnóstico, como la prueba de aglutininas frías. También existen pruebas específicas, como los cultivos, las pruebasserológicasparalamediciónde anticuerpos contra la bacteria gG o gM y la prueba molecular.
Traslarecientepreocupaciónexpresada públicamente por médicos de nuestro país, queentendíanquelainfecciónpor mycoplasma estaba siendo mal diagnosticada debido a los falsos positivos que arroja la prueba serológica en casos donde hubo una infección previa, los Laboratorios Clínicos CostaCaribenosmovilizamosabuscar alternativas para ayudar a la clase médica a realizar un diagnóstico certero.
Dentro de nuestro menú de pruebas tenemos disponiblelapruebademycoplasma pneumoniae molecular, que provee resultados en menos de 2 horas. Este diagnóstico es más específico y menos invasivo. Se utiliza una tecnologíadeamplificaciónisotérmicade ADN para detectar la bacteria, brindando un resultadomáscerteroyev itandolos resultados positivos por infecciones previas. La muestra se toma de la garganta y se puede detectar la bacteria desde el primer día de síntomas.
ueremos que nuestros pacientes reciban un diagnóstico a tiempo y certero, sobre todo en momentos en los que muchas enfermedades respiratorias tienen síntomas similares, como la nfluenza y el C V D- :
Mycoplasma PneumoniaeCOVID-19Influenza
Fiebre x xx
Fa�ga x xx
Tos x xx
Dolor de garganta x xx
Dolor de cabeza x xx
Secreción nasal xx
Dolor corporal y/o cansancio x xx
Diarrea y/o vómito xx
Pérdida de olfato y/o gusto x

La vitamina D o colecalciferol es una vitamina liposoluble que ayuda al cuerpo a absorber el calcio y el fósforo en el intestino y, por tanto, en el depósito de estos en huesos y dientes. Las vitaminas liposolubles son almacenadas en el tejido graso del cuerpo. Esta vitamina se encuentra en distintos alimentos en forma de “precursores” y también puede ser producida por nuestro organismo luego de la exposición a los rayos ultravioletas emitidos por el sol.
Los “precursores” son sustancias que al ser metabolizadas o procesadas por el organismo se convertirán en vitaminas.
Los alimentos tienen distintos precursores como el 7-dehidrocolesterol de origen animal y el ergosterol de origen vegetal. Ambos necesitan de la radiación solar para convertirse en provitaminas.
La luz solar es una fuente importante de vitamina D ya que los rayos ultravioletas dan inicio a la síntesis de vitamina D en la piel.
La vitamina D entonces se deposita en el hígado, cerebro, piel y mayormente en los huesos.
En lo que respecta a su conservación, es una vitamina estable, no es destruida durante la cocción y puede ser conservada durante un largo período.
Funciones
ŸSistema óseo y dentario: el rol más importante de esta vitamina es mantener los niveles de calcio y fósforo normales. Estimula la absorción intestinal de calcio y fósforoysureabsorciónenlosriñones,ala vez que regula el metabolismo de estos minerales, vitales para el crecimiento y desarrollonormaldehuesosydientes.
ŸCrecimiento celular: participa en el crecimientoymaduracióncelular.
Ÿ
Sistema inmune: fortalece al sistema inmuneayudandoaprevenirinfecciones.
ŸHormonas: en conjunto con la hormona paratiroidea, calcitonina (producida por la glándula tiroides) y los estrógenos, la vitamina D mantiene los niveles del calcio.
La vitamina D aumenta la liberación de fósforoycalciodesdeelhueso. Lahormona paratiroidea (PTH o parathormona, producida por las glándulas paratiroides) aumenta la activación de la vitamina D en su forma activa en el riñón. Cuando las concentracionesdecalcioenlasangreson bajas, induce el aumento en la secreción de PTH, mientras que cuando son altas se inhibe su liberación. Su acción está disminuida en caso de carencia de vitamina D. Así mismo la vitamina D intervendríaenlasecrecióndeinsulinadel páncreas, posiblemente a través del mantenimiento de los niveles del calcio en la sangre, el cual es importante para una adecuadasecrecióndeinsulina. ŸSistemanervioso:losnivelesdecalcioson esencialesparalatransmisióndelimpulso nervioso y la contracción muscular. La vitamina D al regular los niveles de calcio en la sangre tiene un papel importante en el funcionamiento saludable de nervios y músculos.
¿En qué alimentos se encuentra la vitamina D? ŸLácteos ŸYemadehuevo ŸPescadoyaceitesdehígadodepescado
Ostras ŸCerealesenriquecidos
Margarinas
¿Cómo ocurre la deficiencia de Vitamina D? Ÿ
La ingesta diaria es menor de los niveles recomendados Ÿ
El riñón no puede transformar la vitamina Densuformaactiva Ÿ
Laexposiciónalsolesinsuciente ŸNo se puede absorber adecuadamente a niveldeltractodigestivo Las consecuencias de la carencia de esta vitamina son: ŸRaquitismoenniños ŸOsteomalaciaenadultos ŸCáncer ŸEsteroides ŸArtritis ŸDiabetes ŸProblemascardiovasculares
La vitamina D también se conoce como la “vitamina del sol” debido a que el cuerpo la produce luego de la exposición a la luz solar. De 10 a 15 minutos de exposición al sol tres veces a la semana son suficientes para producir los requerimientos corporales de esta vitamina. Sin embargo, muchas personas, aún viviendo en climas soleados, no producen suficiente vitamina D y necesitan obtener más de su dieta o suplementos.
Las recomendaciones específicas para cada vitamina dependen de la edad, el sexo y otros factores. Pregúntele al médico cuál es la mejor cantidad en su caso.
¿Cómo medimos la vitamina D en nuestro organismo?
Podemos saber la cantidad de vitamina D en nuestro cuerpo mediante una prueba de laboratorio.




• Covid-19 Antígeno

• CBC
• Influenza
• Mycoplasma a disponi ilidad de reactivo






• Orina
• m arazo y m s Adem s de prue as de seguimiento listas en menos de rs rue as para matrimonio acemos prue as para el Certi cado de Salud esultados vía email al ser solicitado al momento de ser atendido

En el Laboratorio Clínico NBH creemos en el trato personalizado para promover la confianza de nuestros pacientes y estrechar las relaciones con la clase médica.


Contamos con más de 45 años de vasta experiencia en el campo de la tecnología médicaybrindamosunserviciode excelencia y alta calidad.

Nuestro personal está profesionalmente capacitado,poseemosunprograma extensodepruebasparadiagnósticos, equipo tecnológico moderno y avanzado y sistemas computadorizados y actualizados para agilizar los procesos. Además nuestras instalaciones son accesibles, modernas y céntricas.
•Toma de muestras al hogar (por cita previa)
•Análisis clínicos
•Análisis de semen


•Prueba de embarazo
•Prueba de dopaje


•Pruebas para certificados de salud y matrimonio
•Pruebas bacteriológicas
•Prueba de covid 19 antígeno, influenza, mycoplasma
Toda entidad o proveedor de servicio de salud debe aspirar a la excelencia. Los servicios de salud inciden sobre la calidad y expectativa de vida, además de constituir un sector importante de la economía y de la vida en sociedad. Por ende, lo usual es que reciban un alto nivel de respeto comunitario y sean una prioridad en los presupuestos y gestiones gubernamentales, todo lo cual promueve y motiva estos servicios,segúnlosrequieretodasociedad.
En Puerto Rico todo esto fue haciéndose realidad durante el pasado siglo, aún bajo condiciones presupuestarias difíciles, pues en este País abunda el talento, la creatividad y la disposición de servicio a los demás. Así se desarrolló un efectivo sistema de salud pública, tanto gubernamental como privado, que a fines de siglo se extendía por todo el archipiélago, con profesionales comprometidos con proveer servicios de excelencia, aun cuando los presupuestos parecían ser siempre insuficientes.
Pero en este siglo la política pública cambió hacia el modelo de poner a las aseguradoras privadas como intermediarios entre los recursos públicos asignados a la salud y la población que requiere estos servicios. Esos intermediarios fueron extendiendo su control sobre todos los aspectos del sistema de salud, e impusieron la perspectiva de que estos servicios son solo otro negocio sujeto al principio de maximizar ganancias. Esto ha creado una nueva realidad donde ya no tenemos un sistema de salud, sino un sistema de administración de seguros de salud.
El gobierno ha hecho un trabajo muy pobre al administrar ese sistema, donde debía preservarse el interés social de proveerle servicios de salud de excelencia a la población. Para competir entre ellas, las compañías de planes médicos dirigen
millones al mercadeo y a programas que no son propiamente de servicios de salud.
Por otra parte, para continuamente aumentar sus ganancias, limitan las frecuencias de pruebas y tratamientos, y reducen los pagos a los proveedores directos de esos servicios. De ahí las noticias sobre el continuado éxodo de médicos especialistas y las restricciones en disponibilidad de medicamentos y tratamientos. En la industria de los laboratorios clínicos privados muchos se han visto obligados a vender a grandes cadenas o cerrar.
El resultado para la población es que cada día se hace más difícil obtener servicios de salud razonablemente adecuados, no se diga ya de excelencia. Es decir, a pesar de que se han multiplicado los millones disponibles para el sector de la salud, la disponibilidad de proveedores, servicios y productos de reduce constantemente, pues está sujeta al interés monetario de las aseguradoras
La gran mayoría de los pacientes que solicitan los servicios de laboratorio lo hacen utilizando una tarjeta de plan médico. Por ende, el pago que recibirá el laboratorio por sus servicios (personal, materiales, reactivos, etc.) lo determinan los tarifarios impuesto por las compañía aseguradoras. Increíblemente, no obstante los aumentos anuales en costos de operación de los laboratorios clínicos (electricidad, materiales, reactivos, aumentos en salario, etc.), cada año los tarifarios impuestos por las aseguradoras reducen los pagos por las pruebas realizadas. Además, las aseguradoras restringen la frecuencia con que los pacientes pueden hacerse ciertas pruebas, aunque las ordene su médico.
Ante todo esto, y la falta de fiscalización efectiva de las agencias del gobierno, los
laboratorios clínicos extremamos esfuerzos para aumentar la eficiencia sin reducir la excelencia en el servicio. Muchos laboratorios hemos encontrado alternativas bajo el modelo cooperativo para lograr economías en asuntos como compra de materiales, reactivos y servicios de referencia. En la interacción cooperativa hemos también podido discutir prácticas para mantener la calidad y viabilidad de las operaciones, a pesar de que la política pública aún no nos permite negociar colectivamente los contratos y tarifarios con las aseguradoras. En estos momentos de oscuridad en que estamos atrapados por el mercado tenemos que “encender una luz” y ser faro y guía para ayudarnos unos a otros. El cooperativismo nos educa a superar el miedo de “pararnos en nuestros pies” y apostar a nuestra gente y a nuestro País, estimulando así una economía solidaria basada en el apoyo mutuo. El concepto cooperativista nos permite vernos, a los dueños de laboratorios, como compañeros proveedores de servicios y no como competidores; así ganamos todos. El laboratorio clínico cooperativista es una entidad con responsabilidad social, que permite que esta responsabilidad la convierta en empresa de excelencia en el servicio. El movimiento cooperativista también puede ayudarnos a promover cambios en la política pública, para impulsar un cambio del sistema actual al modelo de pagador único, para beneficio tanto del pueblo como de los proveedores de servicios de salud.
Así, en tiempos difíciles, el modelo cooperativista puede ayudar a los laboratorios a mantener la excelencia en el servicio al País.



























Somos un laboratorio más allá de tus expectativas en todas las áreas clínicas



oma de muestra en el ho ar lu ar de traba o industrias centro de cuido y otros.
n o de resultados por plata ormas de internet encriptados para se uridad.
Atención especial a todos sus e ámenes cl nicos sean procesados en el laboratorio o en laboratorios en SA para su con eniencia.
Contamos con un e uipo de traba o de e celencia y altamente pro esional en un ambiente amiliar y con able.
eali amos cl nicas multidia nósticas en medicina ocupacional en industrias.
eali amos cl nicas de Certi cados de Salud y opa e por toda la isla
Está tomando Biotina para fortalecer las uñas, pérdida de cabello o mejorar la textura de la piel Puede que algunos de sus resultados de laboratorio seafectenyaquelapresenciadebiotinaen concentraciones altas puede interferir con ciertas pruebas.
La biotina es parte del complejo de vitamina B. Se encuentra en muchos alimentos por lo que se obtienesuficientecantidadenunadieta balanceada.Ladosisrecomendadacomo suplemento es de 0 microgramos mcg para adultos mayores de años, dosis que tienen la mayoría del multivitaminas. Para las embarazadas y lactantes se recomienda mcg.
El uso de biotina en concentraciones altas se ha proliferadoyaquesondefácilaccesoyse promociona como la solución a problemas de la piel, cabello y uñas. Se encuentran productos que contienen desde 2, 00 a 2 ,000 microgramos mcg . Milesdevecesmásdeladosis recomendada Aunquemuchosdeestos suplementos tienen una alerta donde especifica que notifique a su doctor de su uso y antes de hacerse pruebasdelaboratorio,casisiemprepasa desapercibidoonoseledaimportancia . Megadosis de hasta 00,000 mcg son recetadas para el tratamiento de deficiencia de biotinidasa en desorden congénito, esclerosis múltiple progresiva, ciertas alopecias, psoriasis, alcoholismo crónico, entre otros.
Se han realizado estudios que comprueban que existeinterferenciadelabiotinaenmuchas pruebasdelaboratorioprovocandoresultados falsamenteelevadosodisminuidos.Estoes peligroso ya que conlleva a diagnósticos incorrectos y cambios en manejo de tratamientos a pacientes basado en unos resultados que no son los reales. La siguiente es una lista de pruebas que se afectan con el consumo de dosis altas de biotina. No todas tienen el mismo umbral de interferencia, pero desde dosis mayor de ,000 mcg pueden afectarse. Es importante entender que el error en el resultado no es por inexactitud al realizar la prueba sino porque la concentración de biotina en la muestra interfiere con el inmunoensayo.
esultado alsamente disminu do
A P I -1
AC Aller y Speci c I
Anti- AV I M Insulin Anti- c I M astrin Anti- CV Luteini in ormone C-Peptide MM CA 1 - Myo lobin CA 19-9 Myo lobin S A
Calcitonin -MI steocalcin C M Parathyroid ormone Anti-CCP -pro P P Procalcitonin erritin Prolactin S PSA otal C S A Se ormone indin lobulin Anti en SI sA hyro lobulin uman pididymal Protein 4 S uman ro th ormone roponin
esultado alsamente aumentado
Anti- P Anti- hyro lobulin Anti- S eceptor Cortisol A-S i o in stradiol olate ree 4 ree Pro esterone estosterone 4 Vitamin -12 Vitamin
esultado alsamente ele ado o dismunu do dependiendo del tipo de inmunoensayo CA 12 M-MA CA 12 C A
Esta interferencia varía entre los distintos tipos de análisis. Las pruebas cuyo método utiliza en su reacción la estreptavidina, son susceptibles a la interferencia. El grado de la interferencia depende de la cantidad de biotina en la sangre, tipo de prueba, equipo utilizado, metodología y umbral de interferencia. Para confundir aún más, la misma pruebapuedeestarfalsamenteelevadaenun métodoyfalsamentedisminuidaenotro dependiendo del inmunoensayo con que se analiza. Los estudios sugieren que en estos momentos la solución es suspender el consumo de biotina en dosis mayor a ,000 mcg por 2 horas antes de realizarse pruebas de laboratorio. De esta manera sedescartalainterferenciayseobtienenlos resultados reales.
Como ejemplo:
Los siguientes son resultados de una mujer con pérdida de cabello excesiva tomando 20,000 mcg debiotinaaldíalacualfuediagnosticada erróneamenteconlaenfermedaddeGraves. Luego de descontinuar su consumo y realizarse de nuevo las pruebas se obtuvieron los resultados reales los cuales eran completamente normales. Nótese que el resultado tomando 20,000 mcg de biotina al día, el TSH dio un resultado falsamente bajomientraslosotrosestuvieronfalsamente elevados lo que llevó a un error de diagnóstico. omando 20 000 mc d a de biotina
24 hrslue o de descontinuar la biotina
4 hrslue o de descontinuar biotina
Valor ormal S uI ml0.0 0. 21.440.2 -4.2 4 n dl2.9 1.991.0 0.9 -1. p ml6.094. 12. 11.21-4.1 4 u dl1 .126.44 .1-14.1 Ab mI ml4. 41.96 2
Los manufactureros de los sistemas de pruebas están haciendo estudios para reformular los ensayos con interferenciaabiotina,peroestotomarátiempo. Mientras, hay que desarrollar estrategias para orientar a los pacientes. Lo ideal es identificar al paciente que consumebiotinaenaltasdosisantesderealizarle pruebas, si no es posible, tanto los médicos como el personaldellaboratorioclínicotenemosque permanecer atentos.












 Por Delmarie Roldán
Por Delmarie Roldán
Durante el C V D- , muchos profesionales de la salud dieron el máximo, incluso cuando aún no teníamos las vacunas lamentablemente, muchos también huyeron por miedo, desconocimiento o incluso por falta de interés.
Sin embargo, en el Laboratorio Salimar fuimos de los primeros en nuestro pueblo Salinas en realizar las pruebas para el C V D- . Nuestros empleados trabajaron sin parar, incluso horas extras sin descanso, a pesar del poco apoyo del gobierno y la falta de información en sus comienzos.
Así también, la escasez de materiales para ofrecer el mejor servicio a nuestros pacientes y salvar más vidas fue algo que impactó a nuestro equipo. Muchos materiales fueron acaparados por personas o negocios con poco o ningún interés en la salud de nuestro pueblo. A su vez, los costos se encontraban por las nubes, a veces hasta el triple de su costo regular. Las facturas muchas veces eran duplicadas, las entregas eran costosas, limitaban las cantidades, con esperas muy largas o, en el peor de los casos, cancelaban la entrega o llegaban muy tarde. Esto no solo sucedió con equipos de salud y seguridad básicos, como guantes, mascarillas y alcohol, sino también con reactivos y herramientas mucho más delicadas que eran parte esencial para completar nuestros procesos.
tros factores, como brechas laborales, escasez de empleados, falta de espacio en hospitales, protocolos de cuarentena y escasez de fármacos fueron también retos para alcanzar control en los inicios de esta terrible pandemia. Muchas veces recibimos personas de diferentes partes de la isla que no encontraban en sus pueblos o regiones el servicio de pruebas. En muchas ocasiones, nos sentimos preocupados aunque sabíamos que éramos los más preparados, era un gran reto. Temíamos no poder seguir ofreciendo servicios.
Aun así nuestro deber social, profesional y solidario siempre ha sido ayudar a nuestro pueblo, a nuestros pacientes. Junto a los médicos, ofreciendo un diagnóstico certero, preciso y confiable, sentíamos que en algún momento comenzaríamos a tener control. No íbamos a detenernos hasta lograrlo. Nuestros pacientes siempre han sido nuestra prioridad y razón de ser ellos esperan de nuestros servicios para llevar un estilo de vida saludable. En cada paso que damos queremos garantizar seguridad, confiabilidad, eficiencia, rapidez, respeto y reproducibilidad.
Estos momentos en la historia, como la influenza en el 200 y el C V D- , nos enseñan a siempre actuar a la vanguardia y con rapidez antes de que la pandemia nos acabe a nosotros. Personalmente fui rechazada por profesionales de la salud que no estaban preparados para dar servicios precisamente en la pandemia de la influenza por falta de conocimiento, materiales y empleados del campo de la salud. Nosotros exhortamos al gobierno, al Departamento de Salud y especialistas del campo de la salud a crear planes estratégicos con mejores logísticas, administradores y almacenamientos de fármacos, comidas y materiales de salud aptos para situaciones de emergencia.
La población sufrió demasiado, en muchos casos por negligencia de estos factores. Aún hoy vemos un pueblo que sigue sufriendo escasez de empleados, un aumento de población con problemas de salud mental, enfermedades causadas por el C V D- , familias con pérdidas de familiares, escasez de comida, aumentos de costos en artículos de primera necesidad, profesionales de salud que salen fuera por recibir salarios injustos y un Puerto Rico que lleva levantándose de muchas emergencias como lo han sido los terremotos, huracanes y las pandemias.
Necesitamos resiliencia, solidaridad y mejor organización la salud de nuestro pueblo debe ser de gran importancia. El compromiso debe ser de todos en el campo de la salud y de los ciudadanos para lograr un Puerto Rico y un mundo saludable. Tanto mi madre y yo, como dueñas del Laboratorio Salimar, hemos logrado en las dos ocasiones estar listas estas pandemias. Nuestro éxito ha sido en gran parte gracias a nuestro compromiso, planificación, organización y profesionales comprometidos. Nos hemos preparado para seguir manteniendo un patrón de educación continua, equipos en vanguardia, profesionales más preparados y con materiales de calidad, logrando así que siempre el servicio fuera eficiente y de primera para cada uno de quien nos visite.






Análisis clínicos en general


Resultados el mismo día para pruebas de rutina
Pruebas de emergencia y de influenza en 1 hora



Pruebas de micoplasma y de antígeno de Covid-19 en hora y media








Prueba de PCR COVID-19


Resultados enviados por correo electrónico o entregadas a la mano

Pruebas previas al matrimonio
Amplio estacionamiento
Todo tipo de análisis clínicos
Vista a domicilio con cita previa
Con más de 20 millones de álbumes vendidos, Carlos Vives ha contagiado su alegría colombiana a miles alrededor del mundo. Su experimentación rítmica con el tradicional sonido de la cumbia y el vallenato le han convertido en uno de los rostros de la innovación musical en el panorama artístico latinoamericano. Así como por su música, el también actor y empresario es reconocido por su sonrisa y vivaracha manera de llevar la felicidad como bandera. Sobre el bienestar, la paz espiritual y la función social de su carrera artística comparte Carlos Vives con los lectores de BALANCE.

Aunque has tenido la fortuna de viajar y vivir en distintos lugares, haber nacido y crecido en Colombia es una seña inequívoca de tu identidad. Entonces, ¿cómo se define el “bienestar” desde tu comunidad?
El bienestar es lo que todos buscamos, para nosotros y para nuestra familia. En lugares con tanta desigualdad, a veces es como un privilegio. Pero siempre en mi comunidad de Santa Marta la gente encontró la manera de buscar bienestar. Desde la familia más humilde, el deporte, el bienestar, comer bien, comer pescado, en una región como la nuestra, siempre fue importante. El bienestar es algo que todos buscamos y que en mi pueblo siempre la gente ha encontrado. Es la manera para mantenerse bien y para ser feliz, que al final es la meta de todos. Antes de la música, empezaste tus estudios universitarios en medicina. ¿Hubo algo de esta experiencia que te animara a empezar el camino de wellness?
Mi papá era médico y, por supuesto, fue un ejemplo para mí. Cuando terminé de estudiar en el colegio quise hacerlo sentir bien intentando estudiar medicina y entré a los cursos de pre-médico. Me di cuenta que no era lo mío y que las artes me estaban llamando al teatro y la música. Pero, por supuesto, me crié con una familia donde el bienestar era el tema central y la importancia de conocer nuestro cuerpo, cómo funciona y cómo puede estar mejor y cómo uno puede rendir más. Como artista transmites mucha alegría con tu música, enseñando que lavidapuedeserunagranfiesta.¿Cómohacesparaintentar
mantenerte en un estado de felicidad y así manifestarlo en tu música? Ha estado en mi naturaleza la alegría, tal vez, por el lugar donde nací, la gente con que me crié y la música que terminé haciendo, que son expresión de un pueblo alegre a pesar de sus dificultades. Y también a pesar del olvido, siempre está nuestra cultura, nuestra diversidad y la herencia de alegría de nuestro origen español, de nuestra cultura prehispánica, nuestra herencia africana y de todo lo que somos. Por supuesto, creo que todo esto está en mi naturaleza caribe, en mi naturaleza personal. Siempre he tenido la tendencia a que la vida sea alegre, sea sencilla, sea hermosa y valga la pena todo esto.
¿Tienes un mantra o una afirmación que utilices a diario?
Mantra,sí.Unapersonameenseñóasiemprerecordarcosas importantes. Dice: soy amor, soy salud, soy paz, soy alegría. Repetirse eso en los momentos difíciles, cuando te sientas mal, cuando tienes miedo, porque hay una enfermedad, siempre recordarse uno y repetir: soy amor, soy salud, soy paz, soy alegría. Creo en eso.
¿Tienes un ritual para empezar el día con una buena actitud?
Levantarme, hacer ejercicio, despejar la mente antes de ir a trabajar o de un compromiso, salir a correr, a brincar o una clase de boxeo, coger mucho aire antes de empezar el día.
¿Cómo haces para renovarte cuando estás cansado?
Descansar y cambiar un poquito el panorama, hacer cosas sencillas, como ir a un parque, montar en la bicicleta y romper la rutina del trabajo.Conversarenunaesquina,tomarelcaféconalguien, ocuparme de otras cosas me ayuda mucho a recargar. Pero hay un cargado que es impresionante y es estar un rato con los hijos. Los hijos son cargadores de energía y recuerdan a uno y devuelven a uno el poder del niño interior.

Mantener un estilo de vida activo es importante para la salud. ¿Eres fan de algún tipo de ejercicio en particular?
Sí, siempre fui un fan del ejercicio por naturaleza. Mi papá trabajaba para un equipo de fútbol y me crié viendo a deportistas en su disciplina y entrenamiento. Jugué fútbol en el colegio y en la universidad. Así que el ejercicio es algo que me anima. También los ejercicios sencillos de moverse uno en la vida, incluso en la rutina. Trabajo en un edificio y bajo las escaleras, uso menos el ascensor, procuro moverme y caminar. En las ciudades que voy y donde vivo siempre me gusta caminar y siempre estoy activo sin torturarme mucho con rutinas, como sin darme cuenta realmente que todos los días estoy haciendo ejercicio. ¿Cuál es tu go-to song cuando haces ejercicio?
Depende mucho del mood con que uno amanezca. No siempre la canción más rítmica es la que más me gusta. Uso canciones rítmicas de diferentes géneros, de salsa, de nuestro tropipop, canción de parse

criollo, oigo de todo. A veces la inspiración no depende de la rítmica sino del afecto, de los recuerdos que nos traen esas canciones.
Dicen que el bienestar se compone de la mente, el alma y el cuerpo. ¿Hay alguno al cual le prestes especial atención o intentas mantenerunbalanceentretodos?
Todo está conectado. Muchas veces lo físico va a depender de que nuestra alma esté bien, de que estemos bien espiritualmente y de nuestro ánimo, no se puede ver de manera diferenciada.
¿Hayalgúnmaestro,libro,opodcastquetehayaimpactadoenlosúltimosaños?
Sí. Me impresionó mucho Golden Circle de Simon Sinek, que es aparentemente un libro muy empresarial. Pero es un libro que permite que nos demos cuenta que cada proyecto de la vida al final está conectado con una razón de ser, con un sentido profundo. Y es que no somos lo que hacemos, sino la razón por la que hacemos las cosas.
¿Nos podrías compartir algún “breakthrough” positivo que hayas experimentado en tu vida como consecuenciadetuatenciónatupazinterior?
No he sido una persona de imponerme muchos retos en la vida, pero sí de dejarme llevar por el corazón. Hay momentos en que la paz interior me ha ayudado mucho. Por ejemplo, estuve ocho años fuera de la industria, trabajando como siempre en las cosas que me gustan, pero no con una compañía de discos, había dejado de grabar. Al regresar había que presentar un álbum que fuera novedoso e impactante. Eso fue un reto que me puso la vida. Fue un momento muy especial porque al final uno siempre es uno y la vida siempre te va a dar la oportunidad de soñar más allá. Así nació un álbum que se llama “Corazón profundo”, nacieron canciones como Volví a nacer. Por supuesto, esto tuvo que ver con mi estado en ese momento, con la persona que llegó a mi vida y la paz que trajo, la tranquilidad, la esperanza y la fe. Producto de toda esa vivencia fue ese álbum, en el que hay varias canciones exitosas y que marcaron un recomenzar en mi carrera.
Fundaste “Tras la perla” como parte de tu compromiso social con tu comunidad. ¿Cómo ha cambiado estaexperienciatuvida?
Ha cambiado mucho. Trabajo en el territorio donde nací, al que con el tiempo, la música y el trabajo, entendí de manera más profunda. Hoy trabajo para esa comunidad, desde diferentes frentes, para entender sus problemáticas, entender su diversidad cultural. Trabajamos con mucha pasión, con mucho amor, tratando de subsanar cosas que han estado históricamente en tanta desigualdad, en tanto olvido. Esto me ha marcado profundamente, ha dado una razón a mi trabajo.
Como artista tienes la capacidad de influenciar a muchas personas. ¿Hay algún mensaje particular que quierastransmitir?
En los diferentes momentos de mi vida he tenido claro que el trabajo que hacemos como artistas está vinculado a nuestra territorialidad, a nuestra gente. Cuando uno escogió el camino de la música, que yo escogí, ya estaba llamando la atención sobre nuestro territorio y de alguna manera estaba empezando a devolver todo lo que nuestra gente nos ha dado. Creo que es importante esa conciencia.





















alcpr org





• Tu laboratorio trabaja por tu Salud.

• Junto a la Asociación impulsamos proyectos de Ley que ayudan a cada puertorriqueño a que cuente con un mejor Sistema de Salud.
• Nuestro compromiso es ayudar al paciente a obtener mejor calidad de vida en base a los servicios que ofrecemos.
La Asociación de Laboratorios Clínicos de Puerto Rico te invita a tu laboratorio de comunidad porque: PO Box 11603 San Juan, PR 00922



LABORATORIOS DE EXCELENCIA 2023 ÁREA SUR
Del sueño y el esfuerzo de dos jóvenes comprometidos con emprender en su País nació el primer Laboratorio Clínico Irizarry Guasch en San Sebastián. Se trata de la Lcda. Nilsa Irizarry Guasch, tecnóloga médica de profesión, oriunda de Lajas y amante de las ciencias e investigación y su esposo, José R. Sánchez Zayas, mayor de las Fuerzas Aéreas con una maestría en administración de empresas. Ambos unieron su visión y establecieron lo que es hoy una empresa familiar con la misión de contribuir a mejorar los servicios de salud y calidad de vida de los pacientes que confían en sus servicios hace 34 años.
“Dado a nuestro compromiso en ofrecer resultados de laboratorio de alta calidad y confiabilidad, generados por instrumentos de tecnología de primera, nuestra gran familia de laboratorios fue creciendo. Con mucho orgullo y humildad recibimos pacientes de diferentes pueblos que confiaban en nuestros servicios lo que nos motivó a expandir a otros municipios”, versa con gran ilusión la Lcda. Irizarry Guasch. Actualmente, cuentan con 21 laboratorios y 184 empleados en los municipios de Lajas, San German, Sabana Grande, Yauco, Cabo Rojo, Ponce, Juana Diaz, Mayagüez, Añasco, Aguada, Aguadilla, San Sebastián e Isabela.
Este legado de compromiso y ética ha sido transmitido con ímpetu a sus hijos, el tecnólogo médico José R. Sánchez Irizarry y Shirley M. Sánchez Irizarry, abogada con formación empresarial.
Los Laboratorios Clínicos Irizarry Guasch cuentan con instrumentación especializada y su propio laboratorio de referencia que les permite procesar el 96% de las pruebas ordenadas por su médico con resultados en 24 horas en la mayoría de los casos. Ofrecen servicio al hogar y empresa, y cuentan con una aplicación que permite al paciente obtener y almacenar todos sus resultados en su dispositivo móvil.
“Cada día continuamos expandiendo nuestros conocimientos, manteniéndonos a la vanguardia con las nuevas tendencias tecnológicas y monitoreando las condiciones de salud que más están afectando nuestras poblaciones e invirtiendo en la tecnología necesaria para detectar cualquier condición actual o futura. Nuestro norte es asistir a la comunidad médica para mantener una población saludable y lograr una mejor calidad de vida para nuestros pacientes”, expresa la Lcda. Sánchez Irizarry.
Los Laboratorios Clínicos Irizarry Guasch reiteran su lema: “Su salud y satisfacción son nuestra prioridad”.

El Laboratorio Bayaney abrió sus puertas en junio de 1995. Desde entonces, la excelencia de sus servicios y la visión y vocación del Lcdo Rigoberto Robles promovieron su crecimiento. Hoy, consta de tres Laboratorios Bayaney y dos Laboratorios Omarys, ubicados en Yauco, Aguadilla, Hatillo y Camuy.
“Los pacientes y médicos están sumamente satisfechos con la prontitud y excelencia de nuestros resultados clínicos Tenemos pacientes que llevan recibiendo los servicios desde que comenzamos en 1995 y no solo vienen ellos, sino que sus hijos y nietos también nos visitan”, narra el Lcdo Rigoberto Robles
Entre los servicios que ofrecen están las visitas a domicilio a pacientes encamados, visitas a oficinas y al hogar Los Laboratorios Clínicos Bayaney y Omarys cuentan con plataformas digitales para el acceso de los resultados y para que el paciente pueda acceder a todo su récord de pruebas realizadas. Además, ofrecen un menú amplio de pruebas.
“En pruebas de emergencia estamos a la vanguardia de la tecnologia. Contamos con nuestro propio laboratorio de referencia”, indica el Lcdo Rigoberto Robles
Esta es precisamente la misión de los Laboratorios Bayaney y los Laboratorios Omarys: ofrecer un servicio de excelencia en el menor tiempo posible Su visión es crecer y establecer una cadena de laboratorios completamente puertorriqueña al servicio de nuestra población.

Hace 10 años Damián E. Sánchez Irizarry y la Lcda. Melanie Rodríguez, establecieron la compañía DSI Labs, Inc., la cual es propietaria de los Laboratorios Clínicos Costa Caribe.

Actualmente, cuentan con dos laboratorios en Ponce, uno en Cupey y otro en Puerto Nuevo En estos ofrecen pruebas de rutina, coagulación, químicas especiales, vitaminas, dopaje DOT y Non DOT, Influenza, COVID 19 (Ag, Molecular y PCR), Mycoplasma (Molecular e IgG/IgM), pruebas metabólicas, paneles de autismo y pruebas de alergias, entre otras. Cuentan con envío de resultados de forma electrónica a pacientes y médicos que así lo soliciten y una App que el paciente puede descargar para tener accesibles los resultados en todo momento También brindan servicio al hogar, oficina u empresa.
“La meta de nuestra compañía es establecer varias facilidades alrededor de la isla para crear una red de servicio de laboratorio a la vanguardia de nuevas tecnologías que nos brinden resultados de calidad para ayudar a la clase médica a realizar diagnósticos a tiempo y certeros”, comparten los propietarios
Cuentan con un equipo que se distingue por su calidez humana y compromiso, que hace posible la misión de brindar a los pacientes un servicio de calidad y excelencia con un alto sentido de responsabilidad social.
“Nuestra visión es brindar un servicio integral de ayudas diagnósticas con la más alta tecnología y el sistema más sofisticado de información para que el médico pueda realizar un diagnóstico más rápido y preciso y a su vez pueda brindarle al paciente un tratamiento más certero”, añade la Lcda. Melanie Rodríguez, quien destaca que un 70% de las decisiones médicas son basadas en análisis de laboratorios
Los Laboratorios Clínicos Costa Caribe se distinguen por su compromiso, integridad y ética profesional, calidad y precisión, tecnología y calidad humana.


En la década de 1960, el Dr. Domingo Pérez Ortiz, junto a otros médicos del área de Lomas Verdes en Bayamón, atendían a los pacientes desde sus hogares. Para esos tiempos el único laboratorio clínico que existía en Bayamón se encontraba localizado en el centro del pueblo. Fue así como el Dr. Domingo Pérez Ortiz, y su esposa Ivelisse Berdeguer, tuvieron la idea de establecer el Laboratorio Clínico Lomas Verdes. Al tener reconocimiento de buen servicio al paciente, entrega de resultados a tiempo récord y sentido de pertenencia y de familia, ampliaron en 1971 al Laboratorio Clínico Plaza. La Lcda. Ivelisse Pérez y Lcda. Lizbeth Pérez han seguido el legado de su abuela, Ivelisse Berdeguer, fundadora de ambos laboratorios.
“Ambos laboratorios son reconocidos en la comunidad por el sentido de pertenencia y de familiaridad que se siente y se brinda en ambos. Nuestro personal se dedica a brindarle el mejor servicio al paciente, tratándolo siempre con respeto y amabilidad, para así poder cumplir con sus necesidades. Contamos con una clientela leal, y de muchos años. Tenemos pacientes que vienen desde los primeros años que hoy en día son considerados como familia. Ellos han visto crecer a los hijos, nietos, y ahora bisnietos, del Dr. Pérez Ortiz y la señora Ivelisse Berdeguer”, narran.
La misión del laboratorio es brindar un servicio personalizado de excelencia, amabilidad, confiabilidad y confidencialidad. A esto se suma la visión de continuar creciendo, expandiendo y ofreciendo servicios de salud a las comunidades, con la mejor tecnología y siendo aliados de los mejores proveedores de servicio.
El Laboratorio Clínico Lomas Verdes y el Laboratorio Clínico Plaza cuenta con un equipo de calidad compuesto por tecnólogas médicas, secretarias y enfermeras especialistas en flebotomía, quienes se enfocan siempre en dar la milla extra por los pacientes y ofrecer un servicio de excelencia.
Entre los ofrecimientos disponibles se encuentran: análisis clínicos y bacteriológicos, pruebas de paternidad, pruebas de drogas, prueba necesaria para certificados de matrimonio, pruebas de COVID-19, Influenza y Mycoplasma, marcadores de cáncer (brac 1, 2 y otros), servicios a domicilio, entre otros.
“Nos distinguimos en ser el único laboratorio clínico en Bayamón en brindar servicios de excelencia y confiabilidad. Nuestro laboratorio es más que un laboratorio, es un lugar donde el paciente se siente en casa, donde es tratado con un servicio óptimo y de excelencia. Nuestras enfermeras están adiestradas en flebotomía para así realizar una toma de muestra con precisión. Nuestros pacientes reciben sus resultados STAT en menos de 1 hora porque para nosotros, nuestros pacientes son nuestra familia, nuestra vida”, puntualizan.






Desde pequeña la Lcda. Laura Trujillo supo que quería estudiar algo relacionado a la salud. Su fascinación por las ciencias la llevó a estudiar tecnología médica en el Recinto de Ciencias Médicas de la Universidad de Puerto Rico. Tras completar sus estudios, y tener la experiencia profesional de trabajar en los estados de Maryland y Nueva York, regresó a Puerto Rico y asumió el reto de establecer un laboratorio clínico en los hoy Outlets de Montehiedra.
“La chispa de nuevos comienzos se encendió y comenzamos a trabajar para establecer nuestro nuevo proyecto. Me motivaba dejar un legado a mis hijos y contribuir al cuidado de la salud de nuestro pueblo. En el año 1997 finalizamos todos los requisitos necesarios para establecer el Laboratorio Montehiedra. Nos establecimos como un laboratorio clínico de vanguardia acorde con el nuevo milenio. Desde ese momento hemos continuado innovando, añadiendo pruebas al menú que ofrecemos. Siempre pensando en el bienestar del paciente, enfocados en un servicio de excelencia”, relata la Lcda. Trujillo.
El Laboratorio Clínico Montehiedra tiene la capacidad y está acreditado para realizar pruebas en las áreas de hematología, química clínica, endocrinología, bacteriología, serología y otras áreas. Poseen su propia instrumentación para facilitar la mayoría de los resultados en 24 horas, además de contar con el apoyo de laboratorios de referencia en Puerto Rico y Estados Unidos para la realización de pruebas más especializadas.
La misión del Laboratorio Clínico Montehiedra es ser uno de excelencia que ofrezca resultados exactos, precisos, confiables y rápidos a los pacientes y sus médicos dentro de un marco de alta calidad, respeto y calor humano. A su vez, la visión que los mueve es la de ofrecer una gran variedad de pruebas y servicios de alta calidad de manera eficiente, siendo así importantes colaboradores del mejoramiento de la salud del pueblo de Puerto Rico.
“A nosotros nos diferencia nuestra forma de servir, somos empáticos y nuestro equipo le ofrece consistentemente un servicio personalizado. Todos nuestros pacientes son parte de nuestra familia extendida y como familia le tratamos. Dentro de nuestras capacidades también nos gusta educar al paciente, con nuestra experiencia y conocimiento para poder ayudarles en el manejo de sus condiciones”, menciona la Lcda. Trujillo, quien cuenta con un equipo de excelencia.
La palabra bienestar describe el servicio del Laboratorio Clínico Montehiedra, pues entienden la salud como un todo: físico, emocional, mental y social. Es por esta razón que procuran continuar ofreciendo un servicio de excelencia, integrando la calidad humana con los avances tecnológicos para potenciar el mayor bienestar de nuestros pacientes.

Durante 29 años, el Laboratorio Clínico Gordo se ha mantenido sirviendo a los pacientes en la ciudad de Guaynabo con un distintivo trato amable y profesional.
Su fundadora, la licenciada Lillian M. Gordo Carriles, lo estableció en 1993 tras una carrera de trece años como tecnóloga médica en el CDT de Guaynabo. El laboratorio lleva por nombre el apellido de su padre, quien le inculcó el amor por las ciencias y le inspiró para trabajar en el campo de la salud. En el año 2008 expandió sus servicios con una nueva sucursal en el Centro Comercial Apolo. En ambos establecimientos ofrecen análisis clínicos, químicos y bacteriológicos de sangre y otros fluidos del cuerpo.
La misión del Laboratorio Clínico Gordo es contribuir al diagnóstico y tratamiento de los pacientes mediante un análisis confiable y de alta calidad. Para ello, cuentan con un equipo de enfermeras graduadas especialistas en flebotomía, tecnólogas médicas licenciadas y colegiadas, secretarias especializadas en facturación de planes médicos y tecnología, y con los servicios de un consultor clínico.
“Nuestros laboratorios cuentan con alta tecnología para el análisis y procesamiento de muestras. Nos mantenemos a la vanguardia y por eso contamos con un sofisticado sistema de informática que nos permite manejar eficientemente las operaciones. Ofrecemos resultados electrónicos y proveemos información en nuestra web www.labgordo.com y en Instagram @laboratoriogordo”, detalla la licenciada Gordo Carriles.
En el Laboratorio Clínico Gordo el compromiso es atender a los pacientes en un tiempo prudente y brindar un servicio profesional y de calidad para obtener resultados confiables.


¡La Salud está en nuestras manos! Verdad y consigna que ha guiado la Misión del Laboratorio Las Lomas. Con entusiasmo y compromiso, nos esforzamos día a día para que cada paciente cuente con las pruebas de Laboratorio específicas y los resultados exactos que le permitan “Tomar el control de su Salud”, para mantenerse sanos. Estar sanos o saludables, es más, que no estar enfermos, es el bienestar completo, físico, mental, emocional y hasta social. Que los sistemas corporales funcionen correctamente y cuenten con los recursos para combatir cualquier agente extraño que se acerque y se pueda contar con el cuerpo para todo lo que ocurra día a día. El Laboratorio Las Lomas se llena de satisfacción al poder contribuir con este propósito.
Wilson López-López junto a un excelente equipo de profesionales ha desarrollado, a través de la experiencia administrativa y el liderazgo, un sistema de servicio enfocado en los pacientes. El contar con modernas facilidades, un compromiso real y equipos de Laboratorio de última generación, los cuales cuentan con la misma tecnología de los que se utilizan en los principales hospitales de Puerto Rico, ha permitido que se pueda servir de forma efectiva a miles de pacientes. Haber realizado más de cinco millones de pruebas, además de mantener una constante comunicación y apoyo con los profesionales de la salud, los cuales se encuentran satisfechos, nos motiva a continuar enfocados en la calidad y el servicio.
“Mi compromiso como Laboratorio y como parte integral de la columna vertebral de la Salud en Puerto Rico, es ofrecer servicios con la más alta calidad, trato amable y resultados exactos.” *
“La Sangre lo dice todo”. La participación y apoyo en el proceso de diagnóstico esta fortalecido, en nuestro caso, por la variedad de pruebas y la información que ofrecen. Descubrir cómo está el Síndrome Metabólico, identificando el porqué de una intolerancia o una deficiencia nutricional, resulta fascinante y de vital importancia para una vida saludable en todas las etapas. Las pruebas en el Laboratorio Clínico buscan evaluar cambios en la condición de los sistemas corporales y/o apoyan a identificar condiciones de salud, planificar o evaluar tratamientos y monitorear enfermedades. Todo es posible debido a que se proporcionan datos específicos, validados y comprobados.
El compromiso con que cada experiencia en el Laboratorio Las Lomas sea una de plena satisfacción ha permitido aprender de cada
desafío y convertirlo en un escalón para el desarrollo personal y profesional. El compromiso con la salud, la comunidad y el medio ambiente les llena de satisfacción y les permite aportar al desarrollo social de Puerto Rico. El Servicio en el Hogar a organizaciones variadas e instituciones educativas valida este compromiso con la comunidad.
El compromiso de ser un Laboratorio completo en pruebas clínicas de rutina y funcionales ha permitido desarrollar una cultura de apoyo al paciente y al profesional de la salud para un cuidado integral y para la medicina preventiva.
Con este propósito en mente, no se ha escatimado en esfuerzos para llevar el mensaje de la importancia de mantener una buena salud. Por más de 10 años el Laboratorio las Lomas ha sido proponente y vocero de mantener una salud óptima. Conferencias, talleres y participación en programas de radio han permitido llevar el mensaje, impactando a miles de personas, que una y otra vez agradecen este gesto de amor y compromiso.
Ofrecer soluciones específicas para casos especiales es otra meta del Laboratorio Las Lomas, al buscar siempre tener disponible la prueba que necesita el paciente. Esto se ha logrado con un profundo compromiso del deber y aplicando las habilidades y virtudes de todo un Equipo de trabajo. Tecnólogo(a)s Médicos, Enfermero(a)s, Asistentes Administrativos, Facturadoras, personal de Mantenimiento, Gerentes y Administradores en una misma sintonía han generado la sinergia que nos ha conducido al éxito alcanzado hoy.
“Estoy comprometido con establecer asociaciones profesionales y alianzas estratégicas, mientras se crea un ambiente de trabajo profesional que fomente y reconozca la contribución individual, el trabajo en equipo, el crecimiento y el aprendizaje.” *
Clientes y amigos dan fe del compromiso con el servicio al paciente que existe en el Laboratorio Las Lomas. Suplidores y recursos testifican de las habilidades administrativas y de sanidad financiera de esta organización familiar, netamente puertorriqueña. Orgullosos, todos, del surgimiento de una segunda generación, en la familia, de profesionales de la salud que se apasionan con el servicio al prójimo y pueden sentir el placer de entregar de si, por los demás.

La licenciada Lidia Córdova hace 44 años trabajaba sola en un laboratorio pequeño donde se le presentó la oportunidad de desempeñarse como tecnóloga médica. El esposo de la licenciada Lidia Córdova es un hombre visionario, creyó en las habilidades de la licenciada como profesional en el mundo de las pruebas diagnósticas. Mutuamente se motivaron a comenzar su laboratorio con equipos pequeños y luego ampliaron a equipos más especializados y complejos. Siempre se vio ayudandoa la gente de su pueblo.
El laboratorio lo estableció el Dr. Rafael Córdova PhD en microbiología en el 1974. Era un pionero en su campo, en un momento de la historia fue profesor de muchos médicos en el país. La Licenciada lo conoció y el Dr. Rafael siempre la animó a mirar hacia lo nuevo,el futuro de nuestraprofesión.
Cuentan con dos laboratorios los cuales son independientes y tienen su propio equipo,El laboratorio clínico Córdova y el Laboratorio clínico Río Piedras l el cual fue el primero en establecerse. No tienen en mente seguir expandiendo. El Dr. Córdova cuentacon trestecnólogos médicos, tenemosuna administradoray cada laboratorio tiene un director.
“El campo de la salud siempre me llamo la atención, soy inquisitiva, muy detallista y en este campo es una ventaja la ciencia de la medicina diagnostica es muy variada y hay cambios todo el tiempo. Me gusta compartir y dialogar con los pacientes e intentar de entender que les sea pertinente.”
“A Dios gracias, tengo un personal de muchos años y los pacientes ya son familia. como siempre le tratamos de ayudar sea en precios o tiempo de entrega de resultados confiables, nos dan muybuenas notas.”
A partir de hacer pruebas especializadas de inmunología y bacteriología, El laboratorio cuenta con página web, hacen entregas por email y envían mensajes cuando llegan las pruebas de referencia. Garantizamos en el menor tiempo posible en el 90% de las pruebas. El servicio a domicilio es por cita para pacientes del área.
“Con corazón nuestra misión es servir a mi comunidad en todo lo que pueda y que nuestro trabajo sea de alta confiabilidad y profesionalismo, crear un vínculo estrecho con todos los pacientes y médicos que se sienten confiados en su laboratorio.”
“Nuestra visión está dirigida a las innovaciones en el futuro de la tecnología más avanzada para dar un resultado que lleve aun diagnostico lo más acertado y confiable.” “Somos un laboratorio de familia y nuestra meta es entregar lo antes posible y de la mejor calidad. Que sea accesible a la comunidadque servimos.”










Motivada por la oportunidad de desarrollar sus destrezas en la industria y de servir a la comunidad, la Lcda. Olga Torres Maldonado estableció, junto a Rey J. Jiménez Mora, el Laboratorio Clínico San Martín en 1989.
“Siempre quise trabajar en el área de la salud y encontré que la tecnología médica tenía todo lo que deseaba, desde el trato con el paciente hasta procesar las pruebas y ayudar al médico a poder llegar a un diagnóstico certero para el paciente”, cuenta la Lcda. Torres Maldonado.
El Laboratorio Clínico San Martín es uno pequeño y familiar, que se distingue por la excelencia y alta responsabilidad con los pacientes. “Los pacientes han sido fieles a través del tiempo por sentir que el servicio dado a ellos es muy personal y empático”, explica la Lcda. Torres Maldonado.
La misión del Laboratorio Clínico San Martín es ofrecer el mejor servicio a los pacientes con un servicio de excelencia tecnológica y responsabilidad y un trato de cariño y comprensión.

Al terminar estudios en microbiología clínica, tecnología médica y su maestría en ciencias, Carlos González Ayala tuvo la idea de adquirir un laboratorio. Con la ayuda de sus padres, compró el Laboratorio Clínico M. Landrón, cuyo nombre surge de los dueños originales
El Laboratorio Clínico M. Landrón lleva 25 años en el mercado como laboratorio clínico de referencia comprometido con brindar con prontitud y excelencia los análisis de laboratorio a pacientes y clientes. Desarrollar su capacidad tecnológica y maximizar el pleno desarrollo profesional y personal de su equipo es parte de sus compromisos. “Ser el mejor laboratorio de referencia, líderes en tecnología, calidad y servicios de excelencia, satisfaciendo la demanda y necesidades del mercado en análisis de laboratorio mientras contribuimos a mejorar la salud de nuestra comunidad es nuestro propósito”, dice González Ayala.
Actualmente son el único laboratorio de referencia con presencia en las islas vírgenes y británicas. Cuentan con tres oficinas en Puerto Rico: Laboratorio Clínico y de Referencia Landrón (Vega Baja), PR Clinical Reference Laboratory (Manatí) y Laboratorio Clínico Hyde Park (Avenida Piñeiro). “En las islas Vírgenes somos el único laboratorio de referencia y contamos con tres facilidades: St. Thomas Clinical Reference Laboratory (Altona & Welnost), Hevensigth, y Times Center. En adición, estamos asociados con East End Medical Center, localizado en Tutu Mall”, añade González Ayala.
Su servicio se resume en el liderazgo que tienen en el campo de la tecnología médica. “El Laboratorio Clínico M. Landrón está administrado por un sistema automatizado de manejo de muestras, pacientes y resultados. Esto con interfaces en los equipos del laboratorio para el manejo de resultados y la información automáticamente, haciendo la operación más costo efectiva. El liderazgo, capacidad analítica, personal y lo último en tecnología robótica desde la fase pre analítica, procesamiento analítico y post analítica. Nuestra automatización total nos hace únicos en el mercado tanto en Puerto Rico como en el Caribe”, explica el Lcdo. Carlos González Ayala.

El Laboratorio Clínico Otoao nació de la necesidad de servicios de salud que sus propietarios, Luis Collazo Colón y Johanna Nieves Díaz, identificaron en su pueblo de Utuado.
Siempre anhelé tener mi propio laboratorio. Trabajé en varios, como flebotomista y esa experiencia que me ayudó a desarrollarme, no solo en el campo laboral sino a crecer como ser humano. Es ese crecimiento profesional y personal me sirvió como base para la tirarnos a montar un negocio y como ya me sentía plenamente confiada que la experiencia adquirida me iba a ser útil para seguir ese sueño y echarlo hacia adelante junto a mi esposo.
“Nos motivó ver los problemas de salud que enfrenta nuestro pueblo, asociados a los estilos de vida inadecuados, mala nutrición, vida sedentaria, alcoholismo y drogadicción. Cuando observamos las estadísticas de enfermedades nos percatamos que podíamos aportar al desarrollo de un buen diagnóstico, junto a la clase médica, con resultados de laboratorios precisos”, relatan los también administradores, que cuentan con un equipo multidisciplinario de excelencia.
Aunque al momento tienen una única sucursal, entre sus planes se encuentra el expandir sus servicios. Para los pacientes del Laboratorio Clínico Otoao este es uno de calidad, en donde la prontitud y el trato cordial y amable del equipo son distintivos. Así también, destacan la ubicación de sus oficinas, su amplio estacionamiento y limpieza.
El Laboratorio Clínico Otoao, que cuenta con servicios a domicilio, también posee tecnología avanzada. Cuentan con el programa de facturación Tekpro, el cual les permite crear los récords electrónicos y cumplir con los estándares de privacidad y Ley HIPAA para su clientela.
De esta manera, continúan su visión de ser un laboratorio líder en tecnología dirigido a la comunidad, así como su misión de ofrecer servicios de laboratorio clínico con los más altos estándares de calidad.
“Nuestra razón de ser es el ofrecer un servicio en la industria de la salud que cubra las necesidades de nuestro pueblo y pueblos adyacentes. El laboratorio ofrece los servicios de pruebas de hematología, química, urinálisis y serológicas, lo cual satisface las requisiciones más comunes que requiere la población y ordenadas por los médicos”, puntualizan Collazo Colón y Nieves Díaz.

Para la década de 1970 no existía en el pueblo de Quebradillas el servicio de laboratorio clínico De ahí surge la inquietud de establecer el Laboratorio San Rafael, utilizando el nombre del pueblo y de su patrón. Su fundadora, la Lcda. Noelia Nieves López, tuvo la visión de establecer una facilidad de laboratorio clínico para suplir la necesidad de ese servicio de salud en la comunidad quebradillana.
En 1999 la Lcda. Yolanda Arias se unió a su madre, la Lcda. Noelia Nieves, y establecieron el Laboratorio San Rafael 2000 en Isabela. En 2017 adquirió también el Laboratorio Clínico Monroig, en Quebradillas “Hemos crecido como empresa, aumentando las facilidades para mayor servicio y comodidad para los pacientes, quienes se expresan acorde a los servicios que se les brindan ya que se sienten satisfechos al ver que se les escucha y se atienden sus necesidades de salud”, explica la Lcda. Yolanda Arias.
En el Laboratorio San Rafael se procesan el 94% de pruebas de laboratorio ordenadas por los médicos, incluyendo muestras de bacteriología, ofreciendo así un resultado rápido a médicos y pacientes Brindan también servicios a domicilio de lunes a viernes y cuentan con instrumentos de las mejores compañías en el mercado de laboratorios, como Siemens, Sysmex y Abbot. Los resultados se envían en formato HL7 encriptado, electrónicamente
La misión del Laboratorio San Rafael es brindar a sus pacientes un servicio de calidad y excelencia, garantizando confiabilidad de sus resultados y un estricto protocolo de control de calidad. Les distingue la calidez humana, la atención personalizada, la rapidez y precisión. Estar a la vanguardia de la tecnología y contar con personal altamente cualificado es parte de su visión.
“Nuestra dedicación, amabilidad y empatía nos distingue Un servicio de salud pionero en el ámbito del campo de laboratorio clínico con 47 de años de experiencia en Quebradillas nos hace únicos”, puntualiza la Lcda. Arias





El Laboratorio Clínico Arecibo nace de la necesidad de brindar a la comunidad servicios de salud confiable y accesibles en el barrio Saban Hoyos del municipio de Arecibo. Desde su establecimiento en 1992, la inspiración de sus propietarios y equipo de trabajo servir como una mano amiga que ofrece bienestar, confianza y apoyo en momentos difíciles.
“La gente se refiere a nuestro laboratorio como una familia extendida que ayuda y entiende la necesidad en el justo momento. Es impactante escuchar a familias que nos expresan su agradecimiento por haber recibido su diagnóstico y tratamiento a tiempo gracias a nuestra labor”, indica la Lcda. Margarita Cruz González, quien cuenta con un excelente equipo de especialistas en flebotomía, licenciados en tecnología médica, asistentes de laboratorio, enfermeras graduadas y facturadoras certificadas.
La misión del Laboratorio Clínico Arecibo es continuar sirviendo como un laboratorio independiente con un menú expandido de pruebas y tecnología de vanguardia, automatizada y de precisión que les permite mantener una operación eficiente. Entre los servicios del Laboratorio Clínico Arecibo está la toma de muestras en el hogar, lugar de trabajo y clínicas multidiagnósticas en medicina ocupacional.
Todos estos servicios se fundamentan en la vocación de la Lcda. Margarita Cruz González y su equipo de trabajo, a quienes les distingue una completa dedicación, la cual les ha llevado al éxito de cada gestión social y cívica en favor de la comunidad.
“Nos hace únicos nuestra sensibilidad y deseos de servir a otros. Existen cerca de 900 laboratorios clínicos privados en Puerto Rico y estoy segura que ninguno cuenta con la pasión que dedicamos, en mente y corazón, al desempeño de nuestras funciones como trabajadores de la salud y primeros respondedores”, finaliza la Lcda. Cruz González.
El Laboratorio Clínico Arecibo está ubicado en la Carr. # 2 KM 63.1 Bo. Sabana Hoyos y brinda servicios de lunes a viernes, de 7:00 a.m. - 3:00 p.m., y los sábados, de 7:00 a.m. - 12:00 p.m.

LABORATORIOS DE EXCELENCIA 2022
ÁREA NORTE
En 1988, la Lcda. Ilia Toledo visitaba un médico en cuyo alrededor no había un laboratorio que tuviera horario extendido Ya dueña de otro laboratorio en el pueblo de Florida, la Lcda. Toledo, junto a su hermano el Lcdo. Nelson Toledo, decidió establecer un laboratorio clínico con servicio de horario extendido. En 1990 el Lcdo. Toledo le propuso a su hermana ampliar los servicios a laboratorio de referencia, siendo desde hace 34 años el laboratorio de referencia más grande y especializado en todo Puerto Rico
Actualmente cuentan con diez sucursales y 300 empleados, de los que el 71% son mujeres “A nuestro equipo de trabajo les enorgullece ser parte de nuestra gran familia y del éxito que junto a ellos hemos conseguido”, expresan los propietarios
Este equipo brinda servicios a domicilio y le ofrecen servicios de referencia a hospitales, laboratorios clínicos, centros de salud primaria, centros de investigación y universidades, con la tecnología más avanzada e innovadora.

La oportunidad de satisfacer la necesidad de servicios en la zona rural de Quebradillas inspiró la creación del Laboratorio Clínico San Antonio en 2008. La idea surgió del matrimonio compuesto por la licenciada Omayra Vélez Pérez, tecnóloga médica, y el ingeniero Harrison Saavedra Hernández, ambos naturales de Quebradillas y profesionales con experiencia en hospitales y la industria farmacéutica.
“También me motivó el deseo de ayudar a los demás, nacido del ejemplo de mi madre quien era enfermera graduada y laboraba en el CDT de Quebradillas. Además, fui operada de cáncer de tiroides a los 15 años y todas las semanas tenía que visitar el laboratorio, por lo que fui mostrando mucho interés por este campo y posteriormente mi inclinación por la profesión de tecnología médica que culminé con mucho orgullo en el Recinto de Ciencias Médicas. Me satisface compartir con mis pacientes, apoyarles, hablarles y estar con ellos”, indica la Lcda. Vélez.
La confianza de sus pacientes es el distintivo del Laboratorio Clínico San Antonio, cuya misión es ofrecer una atención personalizada con el mayor respeto y profesionalismo y resultados confiables, precisos y en el menor tiempo posible, sostenidos en la mayor ética profesional y el más alto compromiso con la calidad.
El laboratorio ofrece amplios servicios, incluyendo pruebas especiales que son llevadas a cabo con tecnología de avanzada para ofrecer un análisis confiable, preciso y en el menor tiempo posible, ofreciendo resultados en el mismo día en la mayoría de los casos. También ofrecen visitas a domicilio para ancianos, personas encamadas o con dificultad de movilidad.
Además de contar con un equipo enfocado y comprometido, el Laboratorio Clínico San Antonio posee un amplio estacionamiento dedicado exclusivamente para sus pacientes y con rampa de impedidos, así como seguridad para la continuación de operaciones en casos de interrupción de servicio eléctrico.
La visión del Laboratorio Clínico San Antonio en Quebradillas es la sostenibilidad de su servicio de calidad, implementando siempre los más altos estándares de excelencia con un equipo de profesionales altamente calificado.

La Dra. Katherine Dávila Morales siempre deseó ser dueña y directora de un laboratorio clínico en el cual ejercer su peritaje
Al terminar su residencia en Patología Clínica y Anatómica, fue contratada por el Laboratorio de Patología y el Laboratorio Clínico del Hospital HIMA Caguas, donde pudo desarrollar ambas especialidades. “Estando ahí se me ofreció la oportunidad de comprar un laboratorio clínico en Coamo, cuyos dueños originales estaban en etapa de retirarse Fui a visitar el laboratorio y sentí que tenía un gran potencial para desarrollar nuevas metodologías, añadir especialidades, remodelar la infraestructura y modernizar el sistema de datos para desarrollar un buen sistema de control de calidad”, rememora Dávila Morales, quien posee 25 años de experiencia y también dirige el Laboratorio de Patología del Sistema Menonita y el Laboratorio Clínico del Centro de Salud Familiar Menonita en Yabucoa.
En el Laboratorio Clínico Coamo analizan muestras biológicas que contribuyen en el diagnóstico y tratamiento de enfermedades, en las especialidades de química general y especial, endocrinología, hematología, coagulación, microbiología, análisis de orina e inmunología. Cuentan con enfermeras graduadas para la toma de muestras en el laboratorio y también ofrecen servicio al hogar, centros de cuidado de personas ancianas o discapacitadas, escuelas y empresas “Actualmente estamos desarrollando el establecimiento de otra especialidad en el laboratorio, citología, para el procedimiento, procesamiento y diagnóstico de biopsias por aspiración con aguja fina de lesiones tumorales, mayormente de tiroides y ganglios linfáticos, pero también de otras áreas subcutáneas donde el médico detecta que su paciente tiene alguna lesión para descartar o confirmar malignidad. En este procedimiento, que llevo ejerciendo por 20 años, se introduce una aguja en la lesión, dirigida por sonografía, se aspiran células para ser evaluadas e interpretadas bajo un microscopio y se llega a un diagnóstico Es un procedimiento mínimamente invasivo y el diagnóstico se puede hacer rápidamente al momento de hacer el procedimiento”, anunció la Dra. Dávila Morales.


o P o :
• ata Center para crear récord y órdenes de pacientes









• Permite a adir hasta tres médicos en una misma orden


• n o de acturas electrónicas a tra és de nuestro S VIC




• Aplicación de cobros a planes médicos: econciliación automática y manual
o n e :




• n o de resultados al médico récord médico electrónico planes médicos y al paciente
• n o de órdenes y recibo de resultados electrónicamente de S los laboratorios de e erencia
• Compatible con todas las entidades ue mane an órdenes y resultados electrónicos
e p r o I n c n o s alidad a nuestros Contamos con el tres módulos de estos son Pro ab e P o c o
o A :
• eta
• Control de Calidad
•
• In uen a
• Linealidad
• Mantenimiento Pre enti o
• QC de rina
• éplica de ematolo a y Serolo a
ce o Con a osdeexperienciaenTe pro Inc nos enfocamos en proveer un servicio de calidad a nuestros clientes mediante la programación Contamos con el programa Te pro Sistemas ue incluye tres módulos de traba o para los laboratorios cl nicos estos son Pro ab ab in er y uas te
te proinc
1 ve scorial San uan om entas com
propr com ventas te propr com

Tras varios años de experiencia en laboratorios clínicos y en el sector farmacéutico, la Lcda Debra A Velázquez Webb estableció en 2010 el Laboratorio Clínico Camuy. Además del nacimiento de su hija en 2007, el establecimiento de este laboratorio es el resultado de más de 26 años de experiencia y de una vocación por la ciencia que empezó desde niña.
En el Laboratorio Clínico Camuy realizan todo tipo de pruebas de laboratorio, ya que son un laboratorio de alta complejidad. Realizan pruebas de Mycoplasma, Influenza A y B, Covid 19, pruebas de embarazo, serología, urianálisis, hematológicas y químicas generales y químicas especiales con tecnología avanzada. Así también, realizan pruebas para el certificado de salud y ofrecen servicios de laboratorio a domicilio y a las empresas del país
“Nuestra misión es el compromiso con la calidad, eficiencia de los resultados, respeto, responsabilidad, profesionalismo”, explica la Lcda. Velázquez Webb. Ofrecer los servicios de laboratorio clínico con la más alta calidad y profesionalismo en el menor tiempo posible es parte de su visión, así como mantener el compromiso con la puntualidad, la calidad, el trabajo en equipo, la responsabilidad, la integridad y la buena comunicación.
Sobre sus servicios los pacientes destacan el buen equipo y el trato amable que proveen. “Nos dan las gracias por siempre estar ahí para ellos Nos preocupamos que nuestros pacientes se sientan a gusto en nuestro laboratorio y los ayudamos en todo lo que podamos ayudar y lo hacemos de corazón con mucho cariño. Nuestros pacientes son como familia para nosotros”, comparte la Lcda. Velázquez
De esta manera, el Laboratorio Clínico Camuy se distingue por el compromiso con sus pacientes, la pasión por el trabajo y la calidad del servicio que ofrecen con calor humano y familiar

La historia detrás del Laboratorio clínico El Viví ha sido una ligada al servicio de la salud. La Tecnóloga médica con un doctorado en ciencias biomédicas y especialista en desarrollo de pruebas, la Dra. Kareni J Pérez Torres, tiene una vasta experiencia en el campo de la tecnología médica, trabajando en múltiples hospitales de Puerto Rico por más de quince años Posteriormente continuo sus estudios doctorales en Ciencias Biomédicas en Ponce Health Science University Colaborando a su vez en el desarrollo de laboratorios clínico y de patología de P.R., con la comunidad científica del país y también alrededor del mundo para el desarrollo de vacunas, y de pruebas serológicas y moleculares La Dra Kareni ha sido publicada y presentada en artículos y colaboraciones científicas en P.R. y Estados Unidos. El administrador Heriberto Morales Padro ha sido un representante autorizado de servicio por más de doce años con licencia de incapacidad, servicio de salud y propiedad. Trabajando en los medicare advantage y otros servicios de salud.
La experiencia por más de quince años en el campo de la salud los llevó a tomar la decisión de adquirir y establecer un laboratorio clínico Un sueño que se hace realidad gracias a la oportunidad ofrecida por su colega y amigo El Laboratorio Clínico El Viví está localizado en el pueblo de Utuado, pueblo de donde son parte sus raíces, por lo que fue muy especial adquirirlo y brindarle servicio a la bonita comunidad Utuadeña.
Siempre fue su sueño para ellos tener un laboratorio propio en matrimonio, trabajar en conjunto como empresarios, reconociendo lo retante que es hoy día mantener un negocio y mucho más en el campo de la salud. Para El Viví es importante reconocer que se necesita darle más importancia a la salud y ofrecer las herramientas y los servicios necesarios para que las personas se motiven a cuidarse más y que tengan un servicio único, completo y de alta calidad en su mismo pueblo.
“Utuado es un pueblo que cuenta con una población muy alta de personas de edad avanzada y con condiciones de salud crónicas Muchas de estas personas viven retirados del pueblo, inclusive a unas distancias de 30 a 45 minutos Muchas de estas personas visitan a sus médicos cuando tienen alguna recaída o cuando les toca realizarse su chequeo anual. Debido a la falta de laboratorios en el área, se creó un arduo análisis de población y necesidad de la comunidad del pueblo de Utuado. Es entonces cuando el anterior propietario, el Dr. Samuel Rivera Natal, quien actualmente ofrece sus servicios a la comunidad
Utuadeña, adquiere un pequeño laboratorio en la Calle Betances #53, lo reestructura dándole una amplitud con un cómodo estacionamiento, añadiéndole equipos muy sofisticados con alta complejidad, especificidad y sensitividad que hacen de este laboratorio uno de más alta calidad en toda la zona central de Puerto Rico con un personal altamente capacitado”
El Laboratorio Clínico El Viví cuenta con más de 15 años de servicio a la comunidad, ubicados en el pueblo de Utuado, Calle Betances #53, ofreciendo pruebas tales como; la detección de viruses de Influenza y Coronavirus, Micoplasma, dopajes, Química General Química Especial, Hematológicas, Urianálisis entre otros Laboratorio clínico El Viví le gustaría seguir expandiendo para así poder trabajar con todo tipo de muestras y pruebas de laboratorios ofreciéndole a la comunidad Utuadeña un servicio completo en un solo lugar, así todos los resultados de sus pacientes estén a la mano el mismo día y evitar que el paciente tenga que esperar cuando se envían a los laboratorios de referencia.
Durante el tiempo que llevan ofreciendo servicios se percataron de que hace falta ofrecer más servicios en un solo lugar, es por esto que cuentan con equipos de la mas alta calidad y con resultados más precisos, lo que le brinda mas seguridad y confianza tanto al paciente como el doctor que los refiere. “Estamos a la vanguardia de la tecnología en todo momento, tenemos planes de desarrollo de pruebas que serán de gran avance a la detección temprana, prevención y salud de nuestros pacientes, y esa será nuestra meta y premisa siempre ” El servicio de El Viví se define como uno Innovador Además, se diferencian de la competencia ya que cuentan con unas facilidades amplias y modernas con un estacionamiento exclusivo para los pacientes. Por otro lado, es importante destacar que el laboratorio está equipado con una tecnología avanzada para maximizar el tiempo y minimizar errores Sus equipos son de alta complejidad y calidad tanto como los que se encuentran en los hospitales de Puerto Rico, lo que hace que el Laboratorio Clínico El Viví brinde un servicio confiable, rápido y seguro El equipo de trabajo está debidamente adiestrado y cualificado para el recibimiento de sus pacientes dándoles confianza y tranquilidad mientras se les atiende y se le tome sus muestras El paciente es muy importante para ellos y el trato antes, durante y después es su prioridad.

A la Lcda. Lisette Santiago Morales, desde siempre, le gustaron las ciencias. Por ello, comenzó sus estudios universitarios en el 1973 en el Colegio Universitario de Humacao, siendo luego admitida en la Escuela de Tecnología del Recinto de Ciencias Médicas donde obtuvo su licencia en 1977. En 1989, tras varias experiencias profesionales, estableció el Laboratorio Clínico y Bacteriológico Oriental, en Humacao.
“Llevamos 33 años brindando un excelente servicio a nuestros pacientes. Para nosotros es importante obtener un resultado confiable que le brinde al médico la certeza de diagnóstico para un tratamiento y manejo adecuado que mejore la salud del paciente, que es nuestra meta principal”, relata la Lcda. Santiago Morales.
El equipo de trabajo está compuesto por Zulma Ortiz Rivera, asistente administrativa por 20 años, la recepcionista Marielys Delgado, la enfermera Roxanna González Rosado, quien es la principal flebotomista del laboratorio, y a tiempo parcial las enfermeras Mariela de León y Carmen Velázquez. A ellas se suma Ruddy J. Medina, como administrador, y las tecnólogas médicas, la Lcda. Marilú Tosado y Lcda. Alma C. Colón, supervisora general y supervisora técnica, respectivamente.
“Es un excelente equipo de trabajo con alta tecnología, muy comprometido con los pacientes para brindarles un servicio de calidad con gran empatía, para lograr el bienestar de estos. Cada proceso del laboratorio es estrictamente evaluado y supervisado para garantizar la confiabilidad de las pruebas procesadas”, narra la Lcda. Santiago Morales.
La misión del Laboratorio Clínico y Bacteriológico Oriental es aportar en la prevención, tratamiento y cuidado del paciente, facilitando resultados confiables a médicos y pacientes. “Como directora del laboratorio continuamos vigilantes en mantener la calidad y confiabilidad en los análisis ofrecidos bajo todos los estándares de calidad establecidos para seguir obteniendo certificaciones de excelencia bajo los reglamentos federales y estatales. Nos distinguimos por el servicio que le brindamos al paciente con mucho respeto, empatía, amabilidad y siempre orientándolos sobre la importancia de realizarse los análisis para la prevención, tratamiento de condiciones de salud y sobre todo la importancia de la evaluación médica”, puntualiza la Lcda. Santiago Morales.


Hace 25 años, la Lcda. Gloria D. Torres tuvo la idea de establecer un laboratorio clínico en el que pudiera usar sus años de experiencia para educar y servir de forma directa a la comunidad, dando cuidado al detalle, la eficiencia y la atención personal al paciente.
“Hemos crecido a la sombra del cariño y patrocinio de ciudadanos que han sido forjadores de un pueblo lleno de historia, personas que se han convertido en nuestra familia y amigos. Esta ha sido la fuerza que nos ha movido a construir unas hermosas y cómodas facilidades en la entrada principal del pueblo, donde nuestros pacientes se sienten acogidos y son tratados con mucho cariño”, cuenta la Lcda. Torres, quien es parte del grupo fundador de la Cooperativa de Dueños de Laboratorios Privados.
El servicio a los pacientes y la comunidad médica es la misión del laboratorio, que cuenta con cinco asistentes administrativos, cuatro tecnólogas médicas, tres enfermeras, un encargado de mantenimiento y el esposo de la Lcda. Torres, que es su más estrecho colaborador.
“Nuestros pacientes siempre salen satisfechos y agradecidos por nuestro servicio. Son exigentes pero siempre comentan sobre la simpatía y paciencia de los profesionales que forman nuestro equipo de trabajo”, destaca la Lcda. Torres.
El Laboratorio Clínico Sangermeño ofrece pruebas de hematología, química, coagulación, endocrinología y diversas pruebas especiales. Su equipo es automatizado y moderno, para hacer el trabajo más ágil y rápido. Brindan servicio a domicilio a pacientes encamados y cuentan con una programación electrónica que facilita la comunicación con los médicos y el envío de resultados a los pacientes.
Ser “el laboratorio del pueblo” es su visión. La eficiencia, la cercanía, el buen trato y la rapidez en el servicio al paciente y a su médico les hace diferentes.
Laboratorios Clínicos Landrón y la empresa Siemens Healthineers se unieron para viabilizar el desarrollo de una moderna y eficiente operación, por medio de la automatización total, en los servicios que ofrece dicho laboratorio en su instalación principal en Vega Baja. Carlos González, presidente y CEO de la corporación Laboratorios Clínicos Landrón y presidente de Puerto Rico Clinical Reference Lab, localizado en Manatí, y también del St. Thomas Clinical Reference en St. Thomas, resaltó la importancia de este desarrollo, primero de su tipo en
Puerto Rico. “En esta automatización todos los departamentos de ahora en adelante son uno solo. Es un solo tubo para todas las pruebas. Eso es lo que nos hace innovadores en el tiempo que estamos viviendo”, sostuvo. El Laboratorio Landrón hizo una inversión millonaria en este nuevo proceso de analizar muestras de laboratorios y también está invirtiendo en personal y recursos para maximizar la operación como laboratorio de referencia en Puerto Rico e Islas Vírgenes. Carlos Morales, gerente de Operaciones y Ventas de Siemens Healthineers, explicó

que la automatización en una fase analítica es un punto diferente a la automatización total. “Por primera vez en Puerto Rico existe un sistema y una cuenta con automatización total en un laboratorio”. González agregó que “el proceso se hace más eficiente cuando tú unes, cuando tienes el equipo necesario para poder unir todos los distintos departamentos en uno solo. Es bien importante mantener la integridad de una unidad, de un solo tubo. Tenemos la gran ventaja de que no son 20 tubos los que te van a sacar en el laboratorio. Te sacan solo uno. Ese único tubo, por tener los mismos requisitos de muestras, podemos hacer diferentes pruebas. No solo se pueden realizar diferentes pruebas utilizando un solo tubo, sino que el laboratorio cuenta con un sistema de almacenaje donde se mantiene esa prueba, por si el médico ordena algún laboratorio adicional”, agregó. Contrastó esa ventaja con la realidad de la mayoría de los laboratorios en la Isla. “En Puerto Rico los laboratorios se dividen por áreas. Hay un área que se llama Hematología, otra es de Urianalisis, la otra es la química, hay autoinmunes… muchos departamentos sueltos. Por eso, cuando vas a un laboratorio, según las pruebas que el médico te ordene, te sacan los tubos de sangre”, dijo. que por ello el proceso es beneficioso también para los pacientes. “Inicia con la llegada del paciente, se atendió, se le cogen las demográficas, y un tubo de sangre para las pruebas. Una vez eso ocurre el tubo pasa al área de recibo, donde el técnico lo va a dirigir al área que necesite. En ese momento el equipo es capaz, mediante un código de barras, de generar 22 pruebas distintas. Tan pronto están los resultados, sale un email al paciente con esos resultados, y al médico también, si lo solicita”.
Laboratorio Clínico Landrón que nos ha dado la oportunidad de traer algo totalmente revolucionario y distinto al mercado”, indicó. Aclara que además de sus funciones en la empresa, es también tecnólogo médico de profesión por lo que entiende el manejo y las interioridades del proceso de lo que ocurre en un laboratorio clínico u hospital.



Indicó que Siemens, en el área de 'Healthcare', es sólida y de alta presencia a nivel mundial. Utilizó esa ingeniería, dijo, para traerla al área
Aseguró González que, con la unión de todos los departamentos, la meta de Laboratorios Landrón es mantener su personal intacto. “Lo que vamos a hacer es mejorar los procesos y hacer varios cambios administrativos para ser más eficientes al mercado exterior”.
Morales explicó, por su parte, las ventajas y cualidades del nuevo equipo. “La parte comercial, que es la que yo cubro como gerente de la
compañía, es buscar soluciones a diferentes clientes. Estamos muy agradecidos de otra área para medir, más en estos tiempos de Covid”. Resumió el funcionamiento del sistema indicando que “ellos reciben la muestra, y a pocos pasos la colocan en un solo punto de entrada que es el Aptio Automation input-output module, que es para entrada y salida. De ahí comienza a moverse a las distintas áreas y luego es almacena- do automáticamente en un sistema de refrigeración con capacidad para guardar hasta 16,000 tubos. Si en algún momento hay que repetir la prueba, con colocar el número de esa muestra, el tubo vuelve a salir y llega al área de análisis”.
Concluyó que aquí tienen el proceso completo. “El Laboratorio Clinico Landrón tiene desde la fase preanalítica (manejo y transporte), la fase analítica con Atellica Solution, los más rápidos que existen a nivel mundial, y finalmente la fase post-analitica que es el almacenaje de la muestra”.
Morales aseguró que lo que hizo Laboratorios Landrón fue un paso proactivo a lo que se avecina y sostuvo que el objetivo de Siemens es continuar dando este servicio a todos los laboratorios que puedan cualificar, recalcando que Atellica Solutions es para el manejo de alto volumen. “Creemos que vamos a revolucionar el mercado”.
Insistió en que se trata de un proyecto complejo, complicado, pero afirmó que “nadie puede actualmente hacer un proyecto tan complejo, tan simple como lo puede hacer Siemens, y eso es por nuestro servicio”.
Reconoció finalmente que el personal de Laboratorios Landrón ha sido clave en el proceso de transición. “La clave del éxito de cualquier transición es la actitud del personal y eso es algo que hay que reconocer también”, señaló.
González compartió con su clientela que dentro de los próximos meses el nombre del Laboratorio Landrón va a cambiar a Puerto Rico Clinical Reference Lab, para facilitar el manejo en Islas Vírgenes, tanto americanas como británicas.

El Laboratorio Clínico Hormigueros abrió sus puertas en 1981 como una respuesta a la necesidad de un laboratorio privado en el pueblo de Hormigueros, que identificó la Lcda. Luz Milagros de la Cruz Cordero, quien lleva 48 años ejerciendo como tecnóloga médica.
“La curiosidad científica me motivó a ejercer la salud en el campo de la tecnología médica. Para mí el microscopio es un mundo maravilloso, gracias a esto obtuve un crecimiento tanto personal como profesional. Es una sensación tan humanamente gratificante ayudar a los pacientes que a través de las pruebas de laboratorio sus médicos puedan ofrecerles un diagnóstico confiable y una mejor calidad de vida”, relata la Lcda. De la Cruz sobre su vocación.
El Laboratorio Clínico Hormigueros es un laboratorio independiente que cuenta con profesionales de excelencia para brindar con esmero y calidad el mejor servicio a sus pacientes. Ofrecen análisis clínicos en química, hematología, bacteriología, inmunología, serología, toxicología, urinálisis, endocrinología, entre otro tipo de pruebas. Ofrecen servicio de sangrado a domicilio a pacientes encamados, hogares y centros de envejecientes que soliciten con cita previa. Además, cuentan con un protocolo para el envío de resultados al correo electrónico con la máxima garantía de confidencialidad.
“Nunca falta la reseña de nuestros pacientes, siempre de gratitud en forma de palabras, mensajes y regalos, desde frutas, galletas, bizcochos, flores y lindas sonrisas, a nuestro comprometido equipo de trabajo. De cariño me llaman Licenciada Millie”, comparte su propietaria. “Durante 41 años estamos brindando a la comunidad nuestros servicios y esto nos hace únicos, la calidad y nuestra trayectoria son mi mejor carta de presentación. Así lo hemos sentido siempre, gracias a nuestros queridos pacientes. A mis empleados, por su ardua labor y compromiso, muchas gracias. A mi amada familia, gracias por permitirme ejercer con tanta pasión mi amada profesión”, añade.

En la primavera de 1962, una joven pareja de tecnólogos médicos, egresados del Recinto Universitario de Mayagüez, regresaron a Puerto Rico tras completar estudios posgraduados en la Universidad de Alabama. Oriundos de la ciudad de Mayagüez, reconocieron la necesidad de servicios de laboratorios clínicos en esta área. Esto los llevó a adquirir un laboratorio patológico, ubicado en la calle Post (ahora Ramon E. Betances) al lado del Hospital San Antonio, y convertirlo en un laboratorio clínico y bacteriológico. Así nació el Laboratorio Gaudier, uno de los primeros de toda el área oeste de Puerto Rico.
Esta pareja era Francisco (Panchi) Gaudier y Esperanza (Esperancita) Pirallo, quienes se dieron rápidamente a conocer por el profesionalismo, cordialidad y amabilidad con que atendían a los pacientes y médicos que les referían. Desde sus primeros años, el propio dueño, Panchi Gaudier, ofrecía servicios a los hogares, al hospital, industrias y hogares de envejecientes. Panchi se destacaba por su generosidad y buenas relaciones profesionales, mientras Esperanza fungía como una excelente administradora.
Aunque al principio solo trabajaban ellos dos y una secretaria, rápidamente fue necesario aumentar el personal. Igualmente, la prole de Panchi y Esperancita creció y tuvieron cuatro hijos. Los hijos mayores también llegaron a ser parte de los empleados del Laboratorio Gaudier, pero fue la única hija, Carmen (Cucha) Gaudier, quien decidió continuar en el negocio tras completar una maestría en administración de empresas.
A principios de 1970, Panchi y Esperancita vieron la necesidad de expandir, así que construyeron un edificio en la Calle De Diego #3, entre los dos hospitales del pueblo, en donde hoy se mantienen. Al mismo tiempo se fueron desarrollando cambios en la industria con respecto a las tecnologías usadas en las pruebas clínicas. En ese aspecto, la familia Gaudier siempre se ha mantenido al día con las nuevas tecnologías asegurando
unos resultados más certeros. Hoy día sus procesos están automatizados desde que llega el paciente hasta el proceso de pruebas, facturación y envío del resultado al cliente.
Los avances en la medicina y las nuevas pruebas en el mercado los mantienen aprendiendo constantemente. Suenfoque siempre ha sido la prevención y detección temprana de enfermedades junto con la educación al paciente sobre cómo mantenerse saludable. También se mantienen al día con los procesos de pruebas de dopajes, ocupacionales, de paternidad (DNA) y genéticas, entre otras.
Lo que siempre movió a sus fundadores era la gran satisfacción de servir al público, de ofrecer servicios con esmero y calidad, de dar la milla extra por resolverle al cliente en un ambiente de seguridad y confianza. Aunque ya Panchi y Esperancita no están, ambos estarían sumamente orgullosos de que hoy día a sus sucesores les sigue motivando esa prioridad de servicio de excelencia.
El futuro los lleva a enfocarse más en la tecnología unida al servicio diligente y existe la esperanza de que una nueva generación en el Laboratorio Gaudier perpetúa el servicio que seguirá excediendo las expectativas de los clientes.
La industria ha experimentado una transformación significativa en estos 60 años. Retos tales como las exigencias gubernamentales, aumento en competencia, facturación a planes médicos y en los últimos tiempos, la pandemia de COVID-19, han cambiado todo el escenario. El Laboratorio Gaudier ha vivido todos estos cambios en la industria y se ha moldeado a ellos para lograr ser lo que es hoy día.
Hoy en el año 2022, han pasado 60 años, dos generaciones, muchas experiencias vividas, mucho aprendizaje y se han brindado muchas muestras de cariño, por lo cual el Laboratorio Gaudier agradece a sus pacientes, médicos, suplidores y empleados.
Conmásdecuarenta añosdeexperiencia sirviendoanuestros pacientes,contamoscon ungrupodetrabajo altamenteentrenadoy cualificadoparabrindarel mejorservicioalpúblico.












Damosanuestros visitantesuntratoamable yamistosoquenos dis�nguedelosdemás.





Para la Lcda. Mayra Báez de Reyes la idea de establecer un laboratorio clínico surgió desde el momento en que comenzó a estudiar tecnología médica. “Me di cuenta que teniendo un laboratorio podía aportar de diferentes maneras en tecnología y conocimiento científico para darle al médico las herramientas necesarias en el diagnóstico de sus pacientes”, relata. En 1993 abrió su primer laboratorio, el Post Center Clinical Laboratory, localizado en el Edificio Post Center. Al año siguiente expandió sus servicios con un segundo laboratorio, el Laboratorio Clínico Asociación de Maestros, localizado en el Edificio de la Asociación de Maestros. Junto a su esposo Iván Reyes, y un equipo de excelencia, operan ambos laboratorios en la ciudad de Mayagüez.
“Nuestros laboratorios están especializados en análisis clínicos y bacteriológicos, pruebas COVID-19, pruebas de alergias alimentarias, pruebas de deficiencias de micronutrientes y pruebas de paternidad, entre otras. Contamos con equipos de alta tecnología y un sistema computarizado adaptado a las necesidades y exigencias de este siglo. Damos servicio a domicilio y certificados de salud a compañías, empresas, hogares de envejecientes y escuelas. Aceptamos la mayoría de los planes médicos y vitales. Este año, estamos cerca de celebrar 30 años de servicio por la salud de nuestro pueblo. Nuestro plan en un futuro cercano es dejarle como legado a futuras generaciones la expansión de nuestros servicios en áreas donde haya la necesidad”, indica la Lcda. Báez de Reyes.
La misión del Post Center Clinical Laboratory y el Laboratorio Clínico Asociación de Maestros es ofrecer servicios de calidad y excelencia para garantizar a los pacientes resultados confiables y precisos respaldados por la más avanzada tecnología. Esto se suma a la visión de ser un laboratorio reconocido en el área oeste por la innovación, integridad y compromiso.
“A través de estos 30 años de servicio hemos hecho la diferencia y nos hace únicos el trato y empatía de nuestro personal con los pacientes. Durante esta pandemia del COVID-19 hemos estado en la primera línea desde el día número uno, nos reinventamos y nos adaptamos a los cambios, dando el todo por el todo para los pacientes. Nuestro legado es hacer la diferencia aportando a la calidad de vida y tratamiento de nuestros pacientes”, finaliza la Lcda. Báez de Reyes.

LABORATORIOS DE EXCELENCIA 2022 ÁREA OESTE
Desde el momento en que decidió estudiar tecnología médica, una de las metas de la Lcda. Jeannette S. Troche García era establecer su propio laboratorio. Al graduarse del programa de Tecnología Médica, el Departamento de Salud le asignó cumplir con su año de servicio público en el Hospital Subregional de Aguadilla Pedro Zamora y allí continuó laborando hasta recibir una oferta de trabajo permanente. En 1996 la corporación que administraba el Hospital Pedro Zamora la seleccionó para cubrir una plaza vacante en el CDT de Añasco. Este cambio la llevó a reconsiderar su sueño de establecer su propio laboratorio, el cual cumplió en 1999 cuando el Laboratorio Clínico La Monserrate abrió sus puertas en Hormigueros. En 2013 se expandieron a un segundo laboratorio en Mayagüez.
En ambos laboratorios cuentan con un excelente equipo de trabajo, que incluye una directora licenciada, seis tecnólogas médicas, una enfermera, tres secretarias y una facturadora. Más allá de las credenciales profesionales, cuentan con el compromiso de sus pacientes a quienes han continuado sirviendo pese a los retos de huracanes, terremotos y la pandemia.
“Somos una familia en nuestra empresa. Celebramos los cumpleaños, las fiestas y nos apoyamos unas a otras en todas las situaciones que ocurren en nuestras vidas. Nuestros pacientes, muchos de los cuales nos han visitado por años, son parte de nuestra familia extendida. Como familia, nos preocupamos de ellos, ya sea con llamadas de seguimiento o visitas al hogar, nos esmeramos para que todos ellos puedan tener sus resultados de laboratorio para sus visitas médicas. De igual forma, siempre estamos agradecidos por los detalles y muestras de cariño que nuestros pacientes a menudo comparten con nosotros”, narra la Lcda. Troche García.
Para agilizar sus servicios, procesan la mayoría de las pruebas en sus laboratorios y cuentan con equipos de vanguardia. También, con un sistema que permite a los pacientes recibir sus resultados directamente a su correo electrónico si así lo prefieren. Ofrecen visitas al hogar, a empresas, escuelas, entidades sin fines de lucro y otras organizaciones, también proveen servicios de clínicas y administran las pruebas requeridas para contratación.
“Como laboratorios independientes, estamos comprometidos en cumplir nuestra misión de brindar servicios de excelencia, calidad y proveerles resultados confiables para un diagnóstico certero a nuestros pacientes. Son nuestros pacientes los que nos motivan a seguir dando el todo por el todo, día tras día, para enfrentar los grandes retos que afectan la industria de salud en Puerto Rico. Al fin y al cabo, es el compromiso y la lealtad de nuestros pacientes las características principales que nos hace resaltar dentro de la industria de la salud”, finaliza la Lcda. Troche García.

LABORATORIOS DE EXCELENCIA 2022 ÁREA OESTE
Lcda. Carmen A. Pérez (QEPD) y el Lcdo. Víctor M. Castillo
El Laboratorio Clínico Castillo se estableció en 1973. Surgió de la idea del matrimonio compuesto por la Lcda. Carmen A. Pérez (QEPD) y el Lcdo. Víctor M Castillo, quienes establecieron el primer laboratorio clínico en Añasco. Desde entonces, llevan 49 años brindando análisis clínicos en el área oeste.
La visión del Laboratorio Clínico Castillo es estar a la vanguardia en los servicios de laboratorio clínico, utilizando los recursos técnicos y humanos más avanzados al momento.

Tecnóloga Médica con 23 años de experiencia Supervisora del Laboratorio Clínico Coamo
Me he desempeñado como Tecnóloga Médica desde el año 2001, y como Supervisora General del Laboratorio Clínico Coamo desde el 2004 hasta el presente. La oportunidad de crecimiento y la confianza brindada por la Dra. Katherine Dávila, ha sido una experiencia de mucho desarrollo profesional que ha permitido mantener con éxito y prosperidad la misión y visión del laboratorio.
En el Laboratorio Clínico Coamo tenemos un equipo de profesionales bien preparados Con esmero ofrecemos diariamente un servicio de calidad que redunda en resultados precisos y confiables para el beneficio de nuestros médicos y de nuestros pacientes
Es de mucho orgullo para mí contar con este equipo de trabajo para lograr cumplir con excelencia los estándares y normas de las diferentes agencias que regulan los procesos establecidos en los laboratorios clínicos. Nos mantenemos innovando y desarrollando servicios y tecnología a la vanguardia de la Medicina de Laboratorio. Nuestro compromiso es y ha sido siempre proveerle a nuestra población el mejor de los servicios de laboratorio clínico y lo hacemos con gran esmero, con profesionalismo y con una gran empatía.


Todo lo que está vivo, vibra.
Así se activa la pintura con el sonido. Al pintarla con su propio sonido que codificó en tema mientras creo la pieza.


Cada obra tiene una composición sonora.
La de esta la puedes escuchar en www.soundcloud.com y busca nini2012. Ahí verás esta imagen y le das click.


1. Mírala sin sonido
2. Conéctate al sonido y verás como tu percepción cambia al sentir la vibración del atardecer en la playa.
Varias oficinas médicas ya tienen obras en sus recepciones y se ha notado un cambio en la actitud del paciente al ser expuestos a la obra y su sonido sanador.
Tranquiliza al paciente como antesala de su visita al médico, lo cual puede ser traumatizante hoy en día…

El Laboratorio Clínico Alfeciza es un laboratorio que lleva sirviéndole a la comunidad de Villalba por 37 años, es uno familiar el cual se compone de su hijo Felipe Cintrón Zayas, administrador, Marlín Colón como tecnóloga médica, la enfermera Liz W. Rodríguez, la hija Daisy Marie Cintrón Zayas ayudante ejecutiva, facturadora Jérica Rivera.
Tienen las mejores facilidades de Villalba con 37 años de experiencia. Cuentan con la confianza del pueblo de Villalba y pueblos adyacentes como Ponce y Juana Díaz. Trabajan de la mano con los médicos para poder garantizar una buena salud para sus pacientes y eso los pacientes lo agradecen, se han ganado el respeto de todos gracias a su experiencia y los servicios que le ofrecen, siempre satisfechos con el trato brindado, los pacientes agradecen la empatía hacia ellos, pues su enfoque es en que la experiencia en el laboratorio sea lo más placentera posible.
Sus pacientes están 100% satisfechos con el servicio, puntualidad, se sienten cómodos con la disponibilidad de amplio estacionamiento y espacio en las facilidades brindando confianza con esto del distanciamiento social.
Ofrecen servicio al hogar, cuentan con tecnología avanzada que ayuda a diferenciarse de la competencia como la máquina de escanear venas, cuando un paciente tiene las venas poco visibles el vein scanner ayuda a facilitar el proceso sin perjudicar al paciente.
Los puedes encontrar en las redes sociales Facebook e Instagram como Laboratorio clínico Alfeciza.
Laboratorio clínico Alfeciza se destaca por ofrecer un Servicio de Excelencia, “Servir a la gente es lo mejor que yo puedo hacer, darle la mejor calidad de trabajo para resolver sus problemas médicos.”
Su misión es “brindar a nuestros pacientes el mejor y más confiable servicio con la tecnología más avanzada, buen trato y rapidez en sus resultados.”
Su visión es “Nos dirigimos a proveer resultados rápidos y confiables con la más alta tecnología, lo cual permite al médico un diagnóstico efectivo para un mejor tratamiento a sus pacientes.”
Lo que los hace diferentes de la competencia son sus 37 años de experiencia brindados a la comunidad “Nos satisface ayudar a nuestros pacientes a sentirse cómodos desde que entran por la puerta.”

LABORATORIOS DE EXCELENCIA 2022
ÁREA SUR
En 1996 la señora Claribet Caraballo Lamboy y el licenciado Gregorio Torres Quiñones emprendieron su proyecto de servicios de salud con alta calidad y un ambiente de familiaridad con el nombre de Laboratorio Clínico Profesional Emanuel, en el poblado Guayabal en Juana Díaz. Ambos, Claribet y Gregorio, contaban con amplia experiencia tanto en hospitales, hospicios de salud y laboratorios clínicos, como enfermera graduada y tecnólogo médico, respectivamente.
Luego de varios meses para cumplir con los requerimientos gubernamentales, abrieron el laboratorio sin tiempo ni dinero para inaugurarlo. Pero con el transcurso del tiempo, aquellos días en los que atendían a pocos pacientes fueron mermando y la cantidad de pacientes aumentó. Para entonces, el matrimonio también tenía la responsabilidad de una familia compuesta por sus tres hijas en etapa escolar.
Al cabo de los años, la localidad original del laboratorio fue expropiada para las mejoras en las vías de acceso entre Juana Díaz y Villalba. Esta situación no desalentó a sus propietarios, quienes comenzaron una nueva etapa con más servicios y pruebas disponibles, y el uso de la plataforma digital “Mis resultados”.
En 2012 inauguraron nuevas instalaciones y en 2018 establecieron una segunda sucursal en el barrio Tijeras en Juana Díaz. Lamentablemente, en 2014, falleció su cofundadora Claribel Caraballo, quien continúa siendo motivación en los corazones de muchos.
Con el afán de continuar ampliando sus servicios, esta empresa familiar, que ha prevalecido ante la adversidad y fiel al compromiso con sus pacientes, está próxima a abrir su tercera sucursal en el barrio Jacaguas del mismo municipio.

LABORATORIOS DE EXCELENCIA 2022
ÁREA SUR
Para Delma Rodríguez Morales la idea de establecer un negocio nunca estuvo en sus planes, pues como hija de comerciantes reconocía el trabajo y sacrificio que esto conllevaba. Sin embargo, motivada por su esposo identificó la oportunidad de adquirir el Laboratorio Salimar y de establecer el Laboratorio del Coco, ambos en Salinas.
La rapidez, profesionalismo, eficiencia y excelencia es la filosofía y lo que define a ambos laboratorios “Estamos comprometidos con entregarles a nuestros pacientes cada una de estas palabras en cada servicio que proveemos Esto solo se obtiene si tenemos las herramientas y tecnología necesarias con el equipo de la mejor calidad y la experiencia de nuestro equipo de trabajo Queremos proveerles un resultado rápido y preciso y somos eficientes en manejo del tiempo y ejecutamos nuestro trabajo con profesionalismo sin dejar al lado la excelencia y la ética de nuestro trabajo”, indica Delma Rodríguez Morales, quien cuenta con un equipo de trabajo compuesto por cuatro tecnólogos médicos, tres enfermeras, una especialista de facturación, un director y un consultor clínico Su visión es “mantener nuestro paso sin comprometer nuestra calidad para proveer el mejor servicio a nuestros pacientes”.
El Laboratorio Salimar ofrece servicios a domicilio para pacientes encamados y clínicas de salud. Cuentan también con un amplio menú de pruebas que se procesan a diario (pruebas de hematología, química de rutina y química especiales) y un porciento que envían a laboratorios de referencia. Cuentan con tecnología de vanguardia y con el servicio de recibo de órdenes médicas y envío de resultados por correo electrónico

La Lcda. Sara J. Toro (Sari Jo) se graduó de la Universidad Católica de Puerto Rico con un bachillerato en Ciencias y estudios en Administración de Empresas. Cursó estudios en la Escuela de Tecnología Médica de la Universidad del Sagrado Corazón en Santurce y completó su práctica en el Centro Médico de Río Piedras. Durante 10 años trabajó en el laboratorio del Hospital Damas, en Ponce. Esta experiencia la motivó a establecer el Laboratorio Clínico La 14, en 1997.
“Gracias a Dios, mi esposo Carlos L. Colón, mis hijos, el personal del laboratorio y los pacientes que han hecho de este laboratorio un laboratorio de la comunidad con trato familiar y de excelencia”, indica la Lcda. Toro.
Este laboratorio independiente ofrece servicios a domicilio, cuenta con equipo de gran calidad y envía sus resultados a través de la plataforma “Mis Resultados”. Cuenta también con un equipo compuesto por administración, tecnólogos médicos, enfermeras y secretarias, que es reconocido entre sus pacientes por su trato amable y profesional.
“Nuestra misión es servir con responsabilidad y profesionalismo para la entrega de resultados confiables y oportunos con alto compromiso a la calidad”, indica la Lcda. Toro, quien posee la visión de ofrecer servicios con alta tecnología y capacitación continua del personal.
Al Laboratorio Clínico La 14 lo distingue su servicio confiable, responsable y con calor humano.

EXCELENCIA EN SERVICIO AL CLIENTE Nuestro laboratorio cuenta con el PREMIO ZENIT el 24 de junio de 2021 galardón más alto en servicios de salud otorgado por la Cámara de Comercio de Puerto Rico. CALIDAD Y EXCELENCIA Tenemos equipos especializados lo cual nos garantiza rapidez Aceptamos la mayoría de los planes Médicos incluyendo Vital de la Reforma de Salud del gobierno de Puerto Rico.



yeldesarrollodesubebé,y tambiénpuededetectarel sexodesubebe.Unanálisis



El Laboratorio Clínico La Providencia ha sido un estandarte de la industria de la salud en Ponce y el área sur durante más de dos décadas
“Desde nuestros años de estudiantes de tecnología médica tuvimos ese deseo de poder ser empresarios en la industria de laboratorios. Nos motivó primeramente el poder brindar un excelente servicio de laboratorio clínico, sin ningún tipo de limitación, en especial tecnológica, soñamos con tener un laboratorio donde pudiéramos estar renovando esa plantilla de equipos de laboratorio con regularidad para siempre tener disponible la instrumentación más moderna en el mercado”, recuerdan Migdalia Torres y William Rosaly, propietarios del laboratorio que cumple 27 años de operaciones este próximo diciembre
La misión del Laboratorio Clínico La Providencia es ofrecer análisis clínicos con un estricto control de calidad para garantizar precisión y confiabilidad, así como un trato humano, gentil y a tiempo. A su vez, comparten la visión de ser líderes en análisis clínicos de laboratorio, equipados con la más alta tecnología de instrumentación y sistemas de informática para un acertado diagnóstico y tratamiento de nuestros pacientes
“Durante este tiempo de pandemia, fuimos los primeros en realizar las pruebas de detección de Covid-19 mediante equipos automatizados Inclusive tuvimos pruebas cuantitativas de anticuerpos para determinar la inmunidad después de la vacuna o después de la enfermedad. En la actualidad también somos parte del proyecto del Departamento de Salud para las escuelas”, comentan sus propietarios.
En el Laboratorio Clínico La Providencia realizan todo tipo de análisis de fluidos corporales, exámenes bacteriológicos, pruebas de rutina, pruebas especializadas, pruebas de paternidad, dopaje para matrimonio, y las requeridas para escuelas y universidades También realiza pruebas automatizadas para condiciones infecciosas Ofrecen servicios al hogar y a compañías en el área de Ponce
Todo unido a un excelente equipo de profesionales, compuesto por cuatro tecnólogos médicos licenciados, una enfermera flebotomista especialista en toma de muestras pediátricas y geriátricas y cuatro recepcionistas. Los profesionales y los equipos de avanzada permiten resultados precisos y en corto tiempo.
El Laboratorio Clínico La Providencia está ubicado en el pueblo de Ponce, en la carretera PR-132 km 24.3 frente a las urbanizaciones Jardines del Caribe y La Providencia. Nuestro horario es de lunes a viernes de 6:00 a.m. a 4:00 p.m. y los sábados y feriados de 6:30 a.m. a 12:30 p.m.

La Lcda. Lilly Jadette Torres Lugo tiene 44 años de experiencia como tecnóloga médica y 37 años como fundadora y dueña del Laboratorio Clínico El Tuque En 1985, su amor a la profesión y su afán empresarial la llevaron a establecer su laboratorio en la comunidad ponceña El Tuque, en donde vio la necesidad de servicios de laboratorio clínico accesibles y de calidad. El laboratorio ha dado servicio a madres, hijos y hasta nietos de una misma familia. Además, de ser pionero en ofrecer servicios a domicilio Han enfrentado y superado múltiples retos, como el huracán María, el terremoto del 7 enero de 2020 y la pandemia del COVID 19. En la pandemia desarrollaron nuevas estrategias para atender a sus pacientes minimizando los riesgos de contagio
El personal del laboratorio ha demostrado su resiliencia en todo momento, recordando siempre los nombres de sus pacientes y estableciendo con estos una relación de empatía. Son profesionales que llevan años sirviendo con mucha dedicación y sensibilidad humana a todos por igual. Son constantes en atender con diligencia y muy diestros en la toma de muestras Todos los días se reciben elogios de los pacientes por lo bien que fueron tratados y por lo limpio, organizado y adecuado de las instalaciones
Tanto el laboratorio como su personal cumplen con todas las leyes y reglamentos federales y estatales que rigen su operación. Continuamente reciben adiestramientos y se someten a pruebas de competencia que validan su conocimiento.
La comunidad médica está muy complacida con los servicios del Laboratorio Clínico El Tuque por la rapidez, variedad de pruebas que realizan, resultados confiables y su accesibilidad.

El Laboratorio clínico Plaza Oasis es una empresa familiar cuyo valor más importante es su recurso humano Fue establecido en 2004 para atender la necesidad de servicios de salud en Santa Isabel y pueblos limítrofes. Con 18 años de trayectoria, el Laboratorio Clínico Plaza Oasis fue reconocido en 2022 por la Cámara de Comercio de Puerto Rico con el galardón más alto que es el Premio Zenit en el sector de la salud.
“Nos hemos dedicado en la trayectoria de servicio de nuestro laboratorio a tener un enfoque donde el paciente se pueda atender y recibir sus resultados de forma electrónica, además de tener su resultado a la mayor brevedad posible La plataforma de pruebas que se realizan en el laboratorio es una amplia que le permite al paciente obtener tanto pruebas de rutina como especializadas”, detalla la Lcda. Alba I. Rivera Torres, a quien le motiva las nuevas tendencias en metodologías para la detección de enfermedades. A propósito de esto, el Laboratorio Clínico Plaza Oasis ha colaborado en proyectos con epidemiología del Departamento de Salud y el sistema de rastreo del municipio de Coamo
“A raíz de la pandemia hemos tenido que introducir nuevos métodos según la FDA y su autorización de uso de emergencia lo ha permitido, para mantener el acceso de servicios de salud en las comunidades Es la calidad humana de nuestro personal la que hace la gran diferencia. Agradezco a mi familia y mis empleados por todo el esfuerzo que día a día brindan a los pacientes que son nuestra razón de ser. El laboratorio clínico de comunidad es la herramienta clave para el diagnóstico y tratamiento de las condiciones de salud”, añade la Lcda. Rivera Torres.
El Laboratorio Clínico Plaza Oasis cuenta con un amplio estacionamiento El horario de servicio es de lunes a viernes, de 6:00 a.m. a 5:00 p.m., y sábados, de 6:00 a.m. a 1:00 p.m. Aceptan la mayoría de los planes médicos, incluyendo la reforma de salud. Hacen visitas a domicilio por cita previa.

Desde que inició sus estudios en tecnología médica, la Lcda. Zamira Vega Bonilla tuvo la ilusión de poseer su propio laboratorio Con el apoyo de sus padres, Ramón Vega Báez y Doris Bonilla Avilés, adquirió en 2005 el Laboratorio Clínico Guánica. “Me motivó a trabajar en el campo de la salud que siempre me ha gustado la ciencia. Aparte, me gusta servir y poder ayudar a los demás y a través de mi profesión lo puedo hacer Mis personas de inspiración para comenzar en este campo de la salud fueron mis tíos, los licenciados Irving Vega Báez y Lourdes Anadón Ruiz, quienes tuvieron un laboratorio clínico privado por más de 25 años”, narra la Lcda. Vega Bonilla.
Con diecisiete años de trayectoria, la meta de este laboratorio, ubicado en la calle San Miguel 42 en el casco urbano de Guánica, es adquirir más equipo especializado y realizar más pruebas para expandir sus servicios.
Su misión es distinguirse por un servicio de excelencia, calidad y confiabilidad, reconociendo lo importante que es para el paciente confiar su salud. A su vez, la visión del Laboratorio Clínico Guánica es ser líderes en el apoyo para el diagnóstico clínico profesional, conformado por un equipo de excelentes profesionales y trabajando siempre para el bienestar de los pacientes de manera eficaz, eficiente y confiable
“Nuestros pacientes se sienten satisfechos con el trato que le brindamos, porque los tratamos como parte de nuestra familia sin dejar de ser profesional. Nuestros pacientes dicen que somos amables, atentos, comprometidos y sobre todo rápidos en cuanto al servicio que ofrecemos. Si tuviera que describir el servicio que ofrecemos a las personas de nuestro pueblo en una palabra sería excelencia, porque nos esmeramos en atender a todos nuestros pacientes por igual, dando el mejor servicio, siempre manteniendo privacidad y nuestra parte humana”, detalla la Lcda. Vega Bonilla.
El Laboratorio Clínico Guánica ofrece servicios de lunes a jueves, de 6:30 a.m. a 3:00 p.m., viernes, de 6:30 a.m. a 1:00 p.m., y sábados, de 7:00 a.m. a 11:00 a.m. Ofrecen resultados de análisis de rutina en 24 horas y si el paciente lo desea pueden recibirlos de manera electrónica. Ofrecen servicio a domicilio y aceptan la mayoría de los planes médicos






LABORATORIOS DE EXCELENCIA 2022
ÁREA SUR
La Lcda. Margi G Martínez Colón, vicepresidenta del Laboratorio Clínico Margimar, siempre estuvo interesada en las ciencias Luego de terminar su bachillerato descubrió el área de la tecnología médica, en la cual se formó. Cuando su padre, el Ing Isidro Martínez Gilormini, supo de su interés en la ciencia, investigación y tecnología le presentó la idea de establecer un laboratorio clínico. Luego de mucho esfuerzo, sacrificio y trabajo, se fundó el Laboratorio Clínico Margimar en 2000, un laboratorio clínico independiente que sirve al público con empatía y calidad.
Su misión es proveer a los pacientes de la comunidad de la Urb Glenview Gardens y áreas adyacentes un servicio de excelencia, confiabilidad y calidad respaldado con calor humano y mucho respeto Para esto cuentan con la más reciente tecnología, con un personal autorizado para prestar los servicios de forma inclusiva. “Este servicio se verá traducido en el apoyo al diagnóstico clínico, diagnóstico diferencial, monitoreo terapéutico y clínico de pacientes, así como el de los miembros de la comunidad para preservar su salud y bienestar”, explica la Lcda. Martínez Colón. “Nuestra meta principal es promover la formación integral de los individuos Alcanzando con esta nuestra visión de ser una compañía reconocida por su compromiso permanente con la excelencia y la calidad de los servicios que ofrece Nos dirigimos a establecer servicios de salud en diversas áreas, para mejorar la calidad de vida de la población a ser servida. Por otro lado, parte de nuestro norte es dar a conocer la importancia y la aportación a la sociedad de nuestra profesión y que la misma sea reconocida”, añade.
En la actualidad, cuentan con servicio a domicilio y estacionamiento. Cuentan con tecnología de avanzada en las áreas de hematología, química clínica, urianálisis, serología, entre otras Procesan y entregan la mayoría de los resultados el mismo día o en 24 horas si las muestras son referidas El laboratorio cuenta con tecnología para enviar los resultados directos a la entidad que lo requiera, bajo los estrictos requerimientos de la Ley de HIPAA. Además, cuentan con un equipo de excelentes profesionales. “Contamos con dos asistentes administrativas que con su profesionalismo y entusiasmo reciben y orientan a nuestros pacientes. Mi esposo, el Lcdo. Luis A. Caraballo Mattei, y esta servidora trabajamos en el área clínica. En el área administrativa aún mi madre colabora con el área de contabilidad y mi hijo mayor, Louis André, que está por culminar sus estudios en el campo de las finanzas y derecho empresarial, ha comenzado a ayudarme en labores administrativas”, detalla la Lcda. Martínez Colón.
La mejor carta de presentación del Laboratorio Clínico Margimar es la pasión con que hacen su trabajo, estando conscientes de que sirven a seres humanos con quienes deben ser empáticos y solidarios

La Lcda. Nilda Borrero Hernández trabajaba en el Hospital de Distrito en Ponce cuando su esposo, Jesús Hernández, quien era gerente en la tienda Franklin’s en Yauco, se percató de la necesidad que había en el pueblo de un laboratorio que se especializó en bacteriología.
“Había otros laboratorios pero enviaban a laboratorios de referencia en San Juan la bacteriología y muchas de las pruebas Mi esposo sabía cuánto me gustaba la bacteriología y que si la procesábamos en nuestro laboratorio en Yauco los médicos no tendrían que esperar una semana para recibir el resultado de un cultivo para poder diagnosticar a un paciente”, rememora Borrero Hernández.
Tras completar los trámites, y con mucho esfuerzo y dedicación, el 3 de enero de 1977 abrió sus puertas el Laboratorio NBH, nombrado así en referencia al nombre de Nilda. El éxito de los primeros cuatro años los motivó a ampliar el local. Fueron visionarios en desarrollar espacios que médicos especialistas podían utilizar por horas, alcanzando hasta 16 especialistas que ofrecían sus servicios al pueblo desde el laboratorio
Actualmente, el Laboratorio NBH, ubicado en la calle Matteo Lluberas #40 en Yauco, cuenta con cuatro tecnólogos médicos colegiados, tres recepcionistas y una enfermera. Jesús Hernández continúa siendo su administrador
“Aún con los adelantos logrados en los 45 años de establecidos, cada día seguimos adquiriendo equipo más sofisticado y siempre a la vanguardia de todos los nuevos adelantos para implementarlos en el laboratorio y seguirle ofreciendo a Yauco y a sus pueblos limítrofes el mejor servicio y los resultados más confiables Hoy en día, como servicio a la comunidad y para orientar a los pacientes sobre distintos temas relacionados a la salud, he preparado unos boletines informativos que han tenido una gran acogida”, cuenta Borrero Hernández, quien descubrió su vocación por este campo a través de su padre, quien fue el administrador del Hospital de la Concepción en San Germán durante 18 años
El Laboratorio NBH se define por su servicio óptimo. Procesan la mayoría de las pruebas de rutina y algunas de las especializadas. Ofrecen servicio a domicilio con cita previa y cuentan con la página www.laboratorionbh.com que contiene información para los pacientes
Ofrecer un servicio de calidad, excelencia y competencia en el análisis clínico para promover una mejor salud, apoyados en casi medio siglo de experiencia, sigue siendo la misión del Laboratorio NBH.

En 1970, la Lcda. Nivia García trabajaba en el Hospital La Concepción como supervisora y fue reclutada por el Dr Edson López para establecer un Laboratorio Clínico en su oficina en San Germán. Al crecer la familia de Nivia con dos niños pequeños decidieron establecerse en Cabo Rojo. Su esposo, Ramón Sosa, quien tenía oficina de bienes y raíces en Cabo Rojo, observó que en este pueblo no había un laboratorio clínico privado, entonces decidieron establecer el Laboratorio Clínico García.
“Gracias al respaldo de los pacientes que hemos tenido por más de 50 años, nos hemos mantenido dando un servicio de calidad y excelencia. Ha sido bien gratificante ser héroes anónimos de muchos pacientes y haber tocado muchas vidas y a su vez ayudar al médico a dar un diagnóstico temprano”, cuenta la Lcda. Nivia García, quien descubrió su vocación por esta profesión a través del ejemplo de la madre de su mejor amiga.
El Laboratorio Clínico García cuenta con la tecnología más avanzada, así como con servicio a domicilio Su misión es ofrecer servicios de alta calidad en pruebas de laboratorio a los pacientes en un tiempo razonable y precios que puedan satisfacer sus necesidades. Para poder ofrecer dichos servicios evalúan la calidad de los reactivos, maquinaria y demás mecanismos para garantizar la alta calidad de los resultados manteniendo su confidencialidad y cumplimiento con las expectativas de los pacientes. Mejorar cada día más manteniendo el personal entrenado con los últimos avances en tecnología y nuevas pruebas es parte de su visión.
Entre sus metas a largo plazo buscan simplificar el tiempo al paciente al solicitar servicios donde los resultados puedan llegar al médico directamente, junto con las estadísticas de resultados anteriores para que así el médico pueda comparar el progreso y cambio en los resultados del paciente
La excelencia en el servicio es el distintivo del Laboratorio Clínico García.

El Laboratorio Clínico C&C surge de la inspiración de sus dueños, Lcdo Rudercindo Caraballo Nieves y Lcda Ingrid L. Cruz Santana, de ser un instrumento a través del cual el paciente pueda alcanzar salud y calidad de vida.
“Desde que comenzamos nuestros estudios en el Programa de Tecnología Médica de la Universidad Interamericana en San Germán se despertó en nosotros el anhelo de poder administrar el escenario desde donde se desarrollaría todo el proceso de atención al paciente, la toma de muestras y el análisis de pruebas Siempre vigilantes de la calidad, pero sobre todo del servicio al paciente Así nació hace 23 años este laboratorio que lleva las letras de nuestros apellidos”, relatan Lcdo Rudercindo Caraballo Nieves y Lcda. Ingrid L. Cruz Santana.
La calidad es lo que define al Laboratorio Clínico C&C. Ubicados en Yauco, ofrecen pruebas de rutina, bacteriología, química especial, dopaje, paternidad, entre otras. También ofrecen servicio al hogar y la más alta y moderna tecnología para el análisis
Brindarles a nuestros pacientes los servicios de la más alta calidad para ayudar en los diagnósticos, pronósticos y monitoreo de tratamientos médicos es la misión del laboratorio “Para lograrlo contamos con profesionales altamente cualificados y dispuestos a ofrecer un servicio de primera con la atención, rapidez y calidad necesaria para la producción de resultados precisos y confiables. Como parte de nuestra visión está ser el laboratorio clínico líder de la comunidad, con el mejor servicio y la más amplia diversidad de exámenes para cumplir con las necesidades de las distintas especialidades médicas”, explican los Lcdos.Caraballo Nieves y Cruz Santana.
El compromiso, empatía y solidaridad con cada uno de los pacientes es lo que distingue a este laboratorio para quienes los pacientes son “nuestra razón de ser”.
•Aceptamos todos los planes médicos,incluyendo la Reforma de Salud.
•Realizamos todas las pruebas de Covid 19 (PCR,Antígeno,Serológica).

•Realizamos las pruebas de Influenza y Mycoplasma.
•Realizamos todas las pruebas rutinarias (Hematológicas,Químicas,Serológicas entre otras).

•Ofrecemos servicio a domicilio (Por cita previa).

labmontehiedra.com
















Horario u a i r 6:00 - 4:00 a o 6:00 - :00


ac o o i o a i i c ico ac rio ico ac rio o a u i oroc amo o o i o cu i o u ro ro io a ora orio o i o r u a o r 48-7 ora a ma or a u r u a o 4 ora ci a u r u a o c r icam orma ura r i a
•Covid 19 Antígeno Influenza A B y ycoplasma resultados el mismo día
•Pruebas de Paternidad pre-natales y post-natales
•Prueba para determinar el se o del bebé a través de la sangre materna
•Pruebas de Perfil de icronutrientes para saber el estado de su sistema inmunológico nivel de antio idantes y de su metabolismo. Se recomienda esta prueba antes de comenzar un régimen para perder peso.
•Pruebas Diagnósticas de Autismo


•Pruebas de Alergias



•Pruebas de Plomo y etales Pesados en Pelo Sangre y Orina


•Pruebas Onocológicas cernimiento de cáncer
•Pruebas de Dopa e
•Pruebas ormonales en sangre y saliva
•Pruebas de IV





Análisis Clínicos y Bacteriológicos Servicio a Domicilio Análisis Clínicos y Bacteriológicos Prueba de Covid 19


Prueba de alergias alimentarias Prueba deficiencias de micronutrientes Pruebas de Dopaje
Prueba de paternidad Certificados de Salud a empresas, negocios, hogar de envejecientes y escuela

SSe considera que un paciente tiene trombocitopenia cuando su contaje de plaquetas es menor a 60,000.
El canal PLT-F, disponible en el analizador Sysmex XN-1000, utiliza un colorante fluorescente específico para plaquetas (oxazina) y extiende seis veces el tiempo del conteo de plaquetas, para mejorar la especificidad en la detección de agregación plaquetaria y mejorar la precisión en conteo de plaquetas bajas.

Debido al uso de múltiples medidas de dispersión de la luz y a la tinción fluorescente, los métodos basados en la citometría de flujo tienen una mayor capacidad para detectar anomalías específicas de la muestra y diferenciar las plaquetas de partículas de tamaño similar.
Esta nueva tecnología de detección de plaquetas, sumada a la detección de Granulocitos inmaduros (IG) y células rojas nucleadas inmaduras, ayuda en la determinación de diversas patologías de la sangre. El contaje de células de la sangre (CBC) tradicional no provee esta información.
Todos estos nuevos parámetros se reportan rutinariamente en los CBC requisados por los médicos, sin que tenga que mediar una orden médica especializada. El analizador Sysmex XN-1000 automáticamente activa el método de fluorescencia al detectar niveles bajos de plaquetas y calcula el valor IPF.
La Fracción de Plaquetas Inmaduras (IPF) es un índice de trombopoiesis, que permite asistir al médico en la determinación de causa y diferenciar el diagnóstico de trombocitopenia con un análisis más variado de las plaquetas bajas. El IPF puede ayudar en la determinación de si la trombocitopenia es causada porque el cuerpo destruye las plaquetas o si es causada por baja producción de plaquetas.
El analizador Sysmex XN-1000 es parte de los equipos de avanzada disponibles en el Laboratorio La Providencia en Ponce.

















Las condiciones tiroideas son más comunes de lo que pensamos. Se estima que más de 20 % de la población en Puerto Rico padece de alguna afección de tiroides, mientras que un estudio reveló que un 33% de las mujeres en Puerto Rico han reportado algún padecimiento de la glándula tiroidea. Por esta razón, la Sociedad Puertorriqueña de Endocrinología y Diabetología (SPED) hace un llamado a la detección temprana y al tratamiento individualizado para controlar los trastornos asociados a la glándula tiroidea.
La tiroides es una glándula en forma de mariposa ubicada en el cuello que es controlada por una glándula en nuestro cerebro llamada pituitaria. Esta glándula produce unas hormonas tiroideas que controlan muchas actividades de nuestro cuerpo que van desde cuántas calorías se queman hasta cuán rápido late tu corazón, yo personalmente lo llamo otro de los motores más importantes de nuestro cuerpo. Los problemas de la tiroides incluyen:

Ÿ
Bocio:agrandamientodela tiroides.
Ÿ
Hipertiroidismo: cuando tu glándula tiroides produce más hormonadelanecesaria.
Ÿ
Hipotiroidismo: cuando tu glándula tiroides no produce la cantidaddehormonasuciente.
Ÿ
Cáncerde tiroides
Ÿ
Nódulos: bultos en la tiroides que pueden ser de diferentes tamaños.
ligada cuando se une a una proteína y T3 libre cuando no se une a nada. La cantidad de estas dos juntas se conoce como T3 Total. Unos niveles altos de T3 pueden indicar hipertiroidismo y unos niveles bajos pueden indicar hipotiroidismo.
La T4 o tiroxina es otra hormona que ayuda al diagnóstico de condiciones como hipotiroidismo, hipertiroidismo o trastornos de la glándula pituitaria. Se puede medir como T4 libre o T4 total. La T4 libre es la forma activa de la hormona que entra en los tejidos donde es necesaria y T4 ligada es la que se une a ciertas proteínas, esto previene que entre a los tejidos. Unos niveles altos de T4 pueden indicar hipertiroidismo y unos niveles bajos pueden indicar hipotiroidismo.
La hormona T4 y T3 actúan en conjunto para regular el uso de energía en nuestro cuerpo.
Ÿ
Tiroiditis:cuandotu glándulatiroidesestáagrandada. Los médicos realizan el diagnóstico con un historial clínico, examen físico y pruebas de laboratorio para la tiroides. En ocasiones si el paciente saliera con nódulos en la glándula tiroides, depende del tamaño, se puede realizar una biopsia. Las pruebas de laboratorio que se pueden realizar para llegar a un diagnóstico son: TSH, T4, T3 y anticuerpos antitiroideos. TSH quiere decir hormona estimulante de la tiroides. Cuando los niveles son demasiado altos (hipotiroidismo) o demasiado bajos (hipertiroidismo) hay algún problema con nuestra glándula tiroides. Otras condiciones o trastornos pueden afectar nuestro valor de TSH.
La prueba de T3 o nivel de triyodotironina se usa para diagnosticar hipertiroidismo, donde se produce exceso de hormona tiroidea. La hormona T3 se presenta como T3
El sistema inmune produce unas proteínas que llamamos anticuerpos, que ayudan a combatir procesos en nuestro cuerpo o sustancias extrañas como virus y bacterias. A veces por error los anticuerpos atacan células, tejidos y órganos, lo cual se conoce como respuesta autoinmune. Cuando los anticuerpos antitiroideos atacan células sanas de la glándula tiroides, entonces esto provoca un trastorno autoinmunitario de la tiroides. Para eso se mide los anticuerpos de la tiroides. Algunos de estos son anticuerpos antiperoxidasa (TPO), que puede diagnosticar enfermedad de Hashimoto o Graves, y anticuerpos antitiroglobulina (Tg), también puede ser un signo de enfermedad de Hashimoto. Acontece un resultado negativo si no hay presencia de anticuerpos y un resultado positivo si hay presencia de anticuerpos antitiroideos.
Algunos de los síntomas pueden ser aumento de peso, ansiedad, piel reseca, intolerancia a temperaturas frías, cambios en el ritmo cardíaco, cambios en estados de ánimo, sudoración, dificultad para conciliar el sueño, problemas gastrointestinales y depresión, entre otros. Consulte con su médico si siente algunos de estos síntomas porque podría ser que su tiroides no esté funcionando correctamente.
Nosotros, como profesionales licenciados de laboratorios, estamos para ayudar a su médico en el diagnóstico correcto realizando las pruebas indicadas.
Servicios:






Ser icio a domicilio Ser icio a empresas ematolo a Qu mica Cl nica Coa ulación acterioló ica Parasitolo a rianálisis Serolo a Inmunohematolo a Plomo Virolo a Pre- matrimoniales opa e Co id- 19 Seoló ica Ant eno Molecular

El melanoma y el cáncer de piel de queratinocitos (KSC) son los tipos más comunes de cáncer en las poblaciones de piel blanca. Las tasas de incidencia de KSC, que comprende el carcinoma de células basales (BCC) y el carcinoma de células escamosas (SCC), son mucho más altas que las del melanoma. El desarrollo de BCC es principalmente la causa de una exposición intensiva a los rayos UV en la infancia y la adolescencia, mientras que el desarrollo de los SCC está relacionado con la exposición crónica y acumulativa a los rayos UV durante décadas. Aunque la mortalidad es relativamente baja, la KSC es un problema creciente para los servicios de atención médica que (1) causa una morbilidad significativa.
El melanoma cutáneo está aumentando rápidamente en las poblaciones blancas, con un aumento % anual estimado de alrededor del 3-7 en las últimas décadas. A diferencia del CCE, el riesgo de melanoma se asocia con la exposición intermitente y crónica a la luz solar. La frecuencia de su (1) aparición está estrechamente asociada con el color constitutivo de la piel y la zona geográfica.

Se estimó que para el año 2022, alrededor de 57,180 hombres desarrollarían melanoma de la (2) piel, mientras que 42,600 mujeres desarrollarían la enfermedad. A partir de 2018, los residentes blancos no hispanos tenían las tasas de incidencia más altas de cáncer de piel entre (2) todas las razas.
Los cánceres de piel basales y escamosos se consideran más comunes y menos peligrosos que los melanomas. Entre los residentes de los Estados Unidos, se ha demostrado que el cáncer de piel es más frecuente entre los hombres que entre las mujeres. El cáncer de piel también es más frecuente entre los adultos mayores, y las personas de 65 a 69 años tienen la mayor carga de enfermedad. Con el tratamiento y la detección temprana, los cánceres de piel tienen una alta tasa de supervivencia. Afortunadamente, en los últimos años los EE. UU. ha visto una (3) reducción en la tasa de mortalidad por melanoma.
Ÿ
Este es el tipo más común de cáncer de piel.
Ÿ
BCC se desarrolla con frecuencia en personas que tienen la piel clara. Las personas (3) que tienen piel de color también contraen este cáncer de piel.
Ÿ
Los BCC a menudo se ven como un crecimiento redondo de color carne, una protuberancia similar a una perla o un parche rosado de piel.
Ÿ
Los BCC generalmente se desarrollan después de años de exposición frecuente al sol o bronceado en interiores.
Ÿ
Los BCC son comunes en la cabeza, el cuello y los brazos; sin embargo, pueden formarse en cualquier parte del cuerpo, incluyendo el pecho, el abdomen y las piernas.
Ÿ
El diagnóstico y el tratamiento tempranos para el BCC son importantes. BCC puede crecer profundamente. Se le permite crecer, puede penetrar en los nervios y huesos, (4) causando daño y desfiguración.
Ÿ
SCC es el segundo tipo más común de cáncer de piel.
Ÿ
Las personas que tienen la piel clara tienen más probabilidades de desarrollar SCC. (3) Este cáncer de piel también se desarrolla en personas que tienen la piel más oscura. Ÿ
SCC a menudo se ve como una protuberancia firme roja, un parche escamoso o una llaga que sana y luego se vuelve a abrir. Ÿ
El SCC tiende a formarse en la piel que recibe una exposición frecuente al sol, como el borde de la oreja, la cara, el cuello, los brazos, el pecho y la espalda. Ÿ
SCC puede crecer profundamente en la piel, causando daño y desfiguración. Ÿ
El diagnóstico y el tratamiento tempranos pueden evitar que el SCC crezca (4) profundamente y se propague a otras áreas del cuerpo.



Ÿ
El melanoma a menudo se llama “el cáncer de piel más grave” porque tiene una tendencia a propagarse. Ÿ
El melanoma puede desarrollarse dentro de un lunar que ya tiene en la piel o aparecer repentinamente como una mancha oscura en la piel que se ve diferente del resto. Ÿ
El diagnóstico y el tratamiento tempranos son cruciales. Ÿ
Conocer las señales de advertencia ABCDE del melanoma puede ayudarlo a (4) encontrar un melanoma temprano.
Se realiza con un examen detallado de la piel y una biopsia de la lesión. Esta muestra se envía a un laboratorio de patología.
1. Congelación: Congelándolos con nitrógeno líquido (criocirugía). El tejido muerto se desprende cuando se descongela.
2. Cirugía por escisión. Este tipo de tratamiento puede ser apropiado para cualquier tipo de cáncer de piel. Su médico corta (extirpa) el tejido canceroso y un margen circundante de piel sana.
3. Cirugía de Mohs. Este procedimiento es para cánceres de piel más grandes, recurrentes o difíciles de tratar.
4. Legrado y electro desecación o crioterapia. Después de extirpar la mayor parte de un crecimiento, su médico raspa las capas de células cancerosas usando un dispositivo con una cuchilla circular (cureta).
Evitar y proteger la piel expuesta del sol (y otras fuentes de luz Ultravioleta) es el principal medio para prevenir el cáncer de piel. La buena noticia es que los estudios muestran que la mayoría de los adultos estadounidenses usan algún tipo de protección de la piel. A continuación, las siguientes recomendaciones principales: Ÿ
Busque sombra, especialmente entre las 10 a.m. y las 4 p.m. ŸEvite quemaduras. ŸEvite el bronceado y las camas de bronceado UV. Ÿ

Cúbrase con ropa, incluyendo un voladizo de ala ancha y gafas de sol anti-UV. Ÿ
Aplicar, todos los días, protector solar de amplio espectro (UVA/UVB) con un factor de protección (FPS) igual o superior a 15. Para pasar varias horas haciendo actividades al aire libre, use un protector solar de amplio espectro resistente al agua con un SPF igual o superior a 30. Ÿ
Aplique 1 onza / 28 gramos (2 cucharadas) de protector solar en todo su cuerpo 30 minutos antes de salir. Vuelva a aplicar cada dos horas, después de nadar o sudar profusamente. Ÿ
Mantenga a los recién nacidos fuera del sol. Los protectores solares solo se pueden aplicar a niños mayores de 6 meses de edad. Ÿ
Examine la piel de la cabeza a los pies cada mes. Acude al médico, cada año, para realizar un chequeo médico profesional de la piel.
(5)
El Sistema de Clasificación de la Piel de Fitzpatrick es un sistema de clasificación de la piel que fue desarrollado por primera vez en 1975 por el Dr. Thomas Fitzpatrick de la Escuela de Medicina de Harvard. Estas clasificaciones de la piel y su adaptación han sido reconocidas y son familiares para los dermatólogos. Para determinar su tipo de piel según Fitzpatrick, nuestra prueba mide dos componentes: disposición genética y reacción a la exposición al sol. Los tipos van desde la piel muy clara (Tipo I) hasta la piel muy oscura (Tipo VI).
Referencias:
1. Leiter,U.,Keim,U.,&Garbe,C.(2020).Epidemiologyofskincancer:update2019.Sunlight,VitaminDandSkinCancer,123-139.
2. Elein,J(2022).NewskincancercasesnumberU.S.bygender2022.Statista.Tomadoel6dejuliode2022.
3. Elein,J(2021). RateofskincancercasesintheU.S.in2018,byethnicity.Statista.Tomadoel6dejuliode2022.
4. AmericanAcademyofDermatology.Typesofskincancer.www.aad.org.Tomadoel6dejuliode2022.
5. AmericanAcademyofDermatology.PreventSkinCancer.www.aad.orgTomadoel6dejuliode2022.
use un protector solar de amplio espectro resistente al agua con un SPF igual o superior a 30.










Por Juan Nieves Rivera, MD, FACC
Cardiólogo Especialista en Fallo Cardíaco y Trasplante de Corazón Puerto Rico Cardiology Centro Cardiovascular de P.R. y el Caribe

El término “insuficiencia cardíaca” se refiere a la incapacidad del corazón en poder bombear suficiente sangre a los demás órganos del cuerpo. Es la causa de hospitalizaciones más común en pacientes adultos y representa una de las causas de muerte más importantes en Puerto Rico y Estados Unidos. Es importante identificar la condición lo más temprano posible, para que las alternativas de tratamiento disponibles puedan ser exitosas, pero muchos pacientes llegan a sala de emergenciaoasumédicoprimarioyacuando la condición está bien avanzada. A continuación, se enumeran las causas más importantes de insuficiencia cardíaca y los síntomasmáscomunes.
Factores de riesgo y causas más comunes de insuficiencia cardíaca:
Ÿ
Hipertensión arterial descontrolada Ÿ Infarto al miocardio y arterias del corazón ocluidas Ÿ
Arritmias cardíacas como la fibrilación auricular Ÿ
Problemas con las válvulas del corazón, particularmente la válvula aórtica y la mitral Ÿ Enfermedades del músculo del corazón (cardiomiopatías) ya sean adquiridas o heredadas, como la amiloidosis, distrofias musculares, defectos cardíacos congénitos, cardiomiopatías familiares genéticas, entre otras.
Ÿ
Abuso de alcohol y otras drogas, como la cocaína y las anfetaminas. Ÿ
Infecciones respiratorias como la influenza y el coronavirus Ÿ
Apnea del sueño
Cansancio y falta de aire al ejercicio mínimo o moderado
Hinchazón en las piernas
Falta de apetito y pobre digestión
Sensación de falta de aire cuando uno se acuesta
Cambios en la frecuencia urinaria
Palpitaciones
Dolor de pecho
Tos frecuente
Aunque puede haber causas agudas de insuficiencia cardíaca, generalmente es un proceso lento que empeora poco a poco con el paso del tiempo. Es posible no tener ningún síntoma durante muchos años. Así que si usted o algún familiar suyo ha tenido alguno de los síntomas arriba mencionados es importante que visite un cardiólogo para que éste le ayude a diagnosticar esta enfermedad, ya que la misma puede llevarle a la muerte si no se trata temprano. El peligro principal de esta condición es que no solo afecta el corazón, sino que se pueden afectar todos los órganos del cuerpo, particularmente los riñones, pulmones y cerebro. ¿Cómo

La mayoría de los médicos pueden hacer un diagnóstico provisional de la insuficiencia cardíaca basándose en la frecuencia de los síntomas arriba mencionados y con un examen físico que demuestre retención de líquido en el cuerpo o pobre bombeo de sangre a las extremidades. Existen pruebas que ayudan al médico a poder identificar con eficaz esta condición. Su médico, particularmente su cardíologo, le puede ordenar alguna de las siguientes:
1. Una radiografía de tórax - puede mostrar si el corazón está agrandado y si hay líquidoenlospulmonesoalrededordeellos.
2. Un electrocardiograma (EKG) - para detectar latidos irregulares (arritmia) y frecuenciacardíaca(pulso).ElEKGtambiénpuedeindicarsielpacientehasufridoun infartoalmiocardioagudoocrónico.
3. Unecocardiograma-Permiteconocercuantasangreestábombeandoelcorazón,si estágrandeysilasválvulasdelcorazónestánabriendoycerrandobien.
4. Uncateterismocardíaco-Permiteidenticary,enalgunoscasos,tratararteriasdel corazónqueesténocluídas.Tambiénpermitemedirpresionesintracardíacas.
5. Resonanciamagnéticacardíaca(MRI)-permiteidenticaryexcluir,deformabien certera,causasimportantesdeinsucienciacardíaca.
¿Cómosetratalainsuficienciacardíaca?
Existen diversos tratamientos que pueden ayudarle a reducir los síntomas y la probabilidad de hospitalizarse o morir de insuficiencia cardíaca. Lo más importante es identificar la condición temprano y comenzar el tratamiento lo más pronto posible. Entre las alternativas terapéuticas que han demostrado ser útiles para tratar la insuficiencia cardíaca tenemos los cambios en el estilo de vida, medicamentos, intervenciones quirúrgicas o mínimamente invasivas y, en casos avanzados, el trasplante de corazón.
Algunos consejos para disminuir su riesgo de padecer insuficiencia cardíaca:
ŸNofumar.
Ÿ
Aprendaacontrolarlapresiónsanguínea,losnivelesdecolesterolyladiabetes. ŸSigaunadietamoderada,bajaencalorías,grasassaturadasysal. ŸLimitesuconsumodealcohol. Ÿ
Limitesuconsumodelíquidos. ŸPésesetodoslosdíasparapoderdetectarunaacumulacióndelíquido. ŸComienceunprogramadeejerciciosaeróbicosaprobadoporelmédico. Ÿ
Realíceseunestudiodedeteccióndelaapneaobstructivadelsueño(AOS),sisospecha que la padece. En los pacientes con insuciencia cardíaca, la AOS puede agravar la enfermedaddebidoalesfuerzoalqueseveexpuestoelcorazónduranteelsueño.
No dude en consultar con su médico si usted cree que pudiera padecer de insuficiencia cardíaca. Un diagnóstico a tiempo podría salvarle la vida.
o Fallo Cardíaco es la causa de hospitalizaciones más común en pacientes adultos y representa una de las causas de muerte más importantes en Puerto Rico y Estados Unidos.

Durante los pasados años la Tecnología Médica en nuestra sociedad ha sufrido grandes cambios y desafíos. Este buen profesional de la salud, que podemos describir como de paciencia infinita, meticuloso y de capacidad crítica, con mucha responsabilidad y consiente del trabajo que realiza con conocimiento de los aspectos e instrumentación de avanzada, imprescindible en la salud puertorriqueña. En fin, es un ser humano que demuestra la calidad de grandeza hacia lo que hace, cómo lo hace y hacia quién es dirigido.
Y aunque la sociedad desconozca en gran parte su función con claridad, de seguro han estado en contacto con un Tecnólogo Médico. Esta profesión es la que efectúa los trabajos experimentales y análisis de exámenes corporales de manera tal que aporten la información necesaria con exactitud y confiabilidad al médico para que el profesional de la salud diagnostique adecuadamente, permita evaluar la evolución de una enfermedad durante el tratamiento y puedan ser utilizados como medida preventiva para conocer el estado de salud de los individuos además de detectar precozmente alguna alteración patológica.
En este rol, el profesional de Tecnología Médica es de gran importancia para nuestra sociedad, pero no solamente se desenvuelve en el área clínica directa al paciente, sino que el competido mercado global en que se encuentran los laboratorios clínicos privados o públicos, llevan a este científico de laboratorio a desempeñarse en distintas facetas dentro del campo laboral, tales como: Investigaciones recientes y de avanzada dentro de las industrias farmacéuticas, en el área de la educación; como profesores universitarios y/o investigaciones, en ventas y consultoría en el área de la salud, gerenciales, entre otras.
Todas estas, llevan a este profesional de la salud a estar en continuo desarrollo cognoscitivo para ofrecer siempre lo mejor de sí ante la sociedad puertorriqueña, pero a la misma vez transformándose socioeconómicamente debido al vertiginoso proceso de poco reconocimiento de la profesión en nuestra era que ha sido provocado en gran parte por las diferentes empresas y/o profesiones de salud y su reñida lucha por sobrevivir Ante estos retos, el Tecnólogo Médico debe ser audaz y decidido a utilizar el arma poderosa de la comunicación para poder defender y
velar por los mejores intereses de la profesión. Se tiene que mover el árbol, no para que se le caigan las hojas sino para recoger los frutos que esta grandiosa profesión por el transcurso del tiempo y como Colegiados en los pasados 50 años le ha brindado a la sociedad puertorriqueña en el campo de la Salud dentro de todas las áreas aplicadas.
La necesidad de educar al puertorriqueño sobre el particular es de suma importancia Los Tecnólogos Médicos se esfuerzan para dar lo mejor de ellos no importa en las áreas que se
encuentren laborando y siempre sin esperar nada a cambio deseando siempre que su recompensa sea el b i e n e s t a r d e l p a c i e n t e q u e r e c i b i ó u n diagnóstico/tratamiento certero por la calidad de los resultados entregados. Sin embargo, para lograr abundar y enriquecer los conocimientos de la importancia de la profesión; la propia tenacidad, voluntad, libertad, fuerza, dignidad, respeto, amor al prójimo, amor a la familia, y sobre todo en ayudar sin esperar nada a cambio para su propia satisfacción y realización como persona; son los mismos atributos que le darán la fuerza que tienen que ejercer para lograr su meta de obtener una eficacia en la comunicación tanto en el entorno empresarial, gubernamental, como social. Mahatma Gandhi decía y cito: "Sé el cambio que quieres ver en el mundo".
Se necesita compromiso de todos los sectores; que envuelva liderazgo, ética, relaciones interpersonales, gerencia, entre otras. Un enfoque distinto, que requiere conocimiento y conceptos apropiados que irradien ideas, asuntos y enfoques nuevos que puedan integrarse para la obtención de una comunicación efectiva empresarial y profesional que vaya enmarcada con fines prácticos. Con esto se intenta conseguir que el Tecnólogo Médico obtenga el reconocimiento e importancia sobre su rol en la sociedad puertorriqueña que tanto queremos.
En este caminar y con muchos tropiezos; nuestra labranza, es la que habla y hablará de nuestros justos reclamos.
(El autor es Presidente del Capítulo Sur, del Colegio de Tecnólogos Médicos de Puerto Rico y miembro del equipo de trabajo del Laboratorio Clínico Margimar, Inc.)

iempre nos preocupa nuestra salud, especialmente cuando se nos menciona el corazón. Y si se trata de una madre con un recién nacido o un niño pequeño, al decirle que tiene un soplo, se asusta y piensa en lo peor para su niño y lo mismo pasa para los adultos. Los soplos cardiacos son sonidos producidos por el flujo de sangre acelerado y agitado, conocido también como sonido turbulento en el corazón. Esto puede presentarse en el nacimiento o en la niñez ,la mayoría son inocentes, congénitos (patológicos), o los adquirido, estos suelen desarrollarse más adelante en la adultez.

Los soplos se escuchan por medio de los estetoscopios y se clasifican en los siguientes: inocentes, funcionales y patológicos (los congénitos). Nueve de cada diez niños va a tener un soplo cardiaco (estos son los inocentes). Al escuchar el corazón, este emite dos sonidos: el primer sonido es producido por las válvulas atrio ventriculares (mitral y tricúspide) y el segundo sonido son por las válvulas semilunares (aortica y pulmonar)
La mayoría de los soplos que se escuchan en los niños son funcionales o inocentes. Esto quiere decir que es un corazón normal, con función y anatomía normal pero la turbulencia de la sangre en el corazón produce ese sonido extra que escuchamos, que es el soplo inocente o funcional. El soplo funcional se escucha tanto acostado como sentado pero su intensidad varía con la posición, se puede escuchar tanto en estado normal o cuando el niño está enfermo, ya que su corazón late más rápido. Según va creciendo su intensidad va reduciendo y luego con el tiempo se deja de escuchar.
El inocente se escucha más fácilmente cuando hay una enfermedad o una condición (por ejemplo: anemia, catarro, etc.) y cuando el niño esta normal, se deja de escuchar. Debemos recordar que el corazón anatómico y funcional y anatómicamente es normal. Ahora vamos hablar de los soplos congénitos, este es debido a anomalías anatómica del corazón, donde uno de cada mil niños puede presentar esta anomalía al nacer. Muchas veces se puede escuchar al nacer pero la mayoría se empieza a escuchar más tarde en la vida. Estos soplos pueden tener varias presentaciones. Esta el niño que presenta cianosis (color purpura) y muchos que presentan al nacer, pero según va pasando el tiempo (a días o semanas) se empiezan a escuchar soplos. Al principio no solo se ve cianótico
pero según va pasando el tiempo se le hace difícil alimentarse y se cansa fácilmente en la acción de chupar y se duermen rápido, respira rápidamente y la ganancia de peso es pobre. Por eso si vez que tu niño no gana peso adecuado, se cansa fácilmente chupando, es un bebe irritable y suda mucho cuando está chupando (en la alimentación) debe de ser evaluado por su pediatra para referirlo a un sub-especialista.
También hay otras condiciones congénitas del corazón que no presenta cianosis al nacer. Si se va a escuchar el soplo y pasa trabajo al respirar, se pueden cansar fácilmente causando que el recién nacido puede tener una pobre succión del seno y no gana el peso adecuado. Entre estas condiciones, encontramos los defectos atrio ventriculares, defectos ventriculares, ductos arteriosos coartación de la aorta, entre otros. Entre los defectos cianosantes tenemos la patología congénita que disminuye el flujo de sangre al pulmón como Atresia Tricuspidia, Atrecia pulmonar y Tetralogía de Fallot. También están los que tienen un flujo alto sangre al pulmón, como Trasposición de los grandes vasos, Truncus arteriosus y Retorno Anómalo Pulmonar, entre otros.
Por eso cuando informan que tu niño tiene un soplo y no presenta ningún síntoma adicional hay que recordar que la mayoría son benigno y no interfiere con la vida y actividad de un niño. Un niño al que se le escucha un soplo debe de ser evaluado de su médico primario y este referirlo a un sub-especialista Cardiólogo Pediátrico donde lo evaluara con la radiografía, una placa de pecho para ver si el tamaño del corazón esta adecuado, un EKG para ver si hay anomalías en el ritmo o si el tamaño del corazón esta adecuado y al final un Ecocardiograma para confirmar la condición escuchada y poder dar el tratamiento adecuado según la condición.
Hay defectos congénitos que necesitan una intervención quirúrgica para poder llevar una vida lo más normal posible. No todos defectos congénitos necesitan cirugía. Están los soplos adquiridos que se ven más en la adultez. Aquí se pueden ver las estrechez de válvulas, como la válvula aortica, siendo la más común afectada, la cual se engrosa o se calcifica según va pasando la edad. Muchas veces en la edad avanzada necesita cirugía cardiaca. También podemos encontrar el prolapso de la válvula mitral que según va perdiendo la coaptación y va presentando más regurgitación de la válvula, la cual muchas veces necesitan, en caso severo, cirugía. Tenemos los que son producidos por infecciones, como es la fiebre reumática y condiciones del colágeno que afectan las válvulas. A diferencia de las condiciones anteriores, están pueden ser asintomática y con el tiempo presentar pobre tolerancia a la actividad física, fatiga al ejercicio y dolor de pecho, si presentan estos síntomas debería de ser evaluado por un Cardiólogo. Por lo tanto, debemos recordar que los soplos tienen diferentes orígenes, en los niños siendo más común el inocente o funcional, donde nueve de cada diez niños se presenta un soplo durante su niñez. Debemos recordar que el niño va a tener una vida normal y hacer actividades normalmente. Todo paciente con un soplo congénito cianosante va a requerir una cirugía para poder llevar una vida lo más normal posible. Niños con soplo congénito no cianosante no siempre requerirá una cirugía pero si la mayoría de ellos. Por lo tanto, toda persona con soplo debe de ser evaluado por su médico primario y este referirlo, si es necesario, al cardiólogo, cuando no es un soplo normal. Recordar que los soplos funcionales son normales, mantener un peso adecuado, hacer actividad física, mantener una buena higiene dental para tener un futuro con bajas complicaciones cardiacas.





omos el primer Laboratorio Clínico privado establecido en ayag ez en el año . ueron sus fundadores el r. rancisco anchi audier y su esposa Esperanza irallo, ambos tecnólogos médicos.
En el Laboratorio audier garantizamos la eficiencia, precisión y confidencialidad de todos los servicios que brindamos. ueremos exceder sus expectativas y estamos comprometidoas con la responsabilidad social de asegurar la salud y la seguridad de nuestros clientes.


Lunes a viernes : A 4: A ábado : A :
Continuamosconelmismocompromisoy esmero que el primer día. Nos orgullece ser el laboratorio más competente y confiable de todo el área este. aya ez E Calle e iego labgaudier gmail.com








LastemporadasdeInfluenzasonúnicaseimpredecibles,eldesarrollode la nueva prueba diagnóstica combinada de Status™ COVID 19/Flu A&Bbuscaatenderambosvirusenunasolatomademuestraalpaciente Según expertos, esta temporada será muy diferente ya que tenemos que combatirsimultáneamentelosvirusInfluenzayCOVID 19
“Estamos en un punto de inflexión importante donde se junta los métodos preventivos y nuevas tecnologías para combatir ambos virus.”, precisó la licenciada Alba Rivera Torres, propietaria del Laboratorio Clínico Plaza Oasis en Santa Isabel y quien cuenta con más de 25 años de experiencia como profesional de la salud. “Es un momento ideal para hacernos una pregunta muy válida, ¿cómo nos preparamos para la primera temporada simultánea de Influenza y COVID-19?”, detalló la licenciada.
La temporada de Influenza, según el CDC, comienza preliminarmente en octubre y puede extenderse hasta mayo. El periodo de mayor número de infecciones reportadas tiende a ser durante el mes de diciembre y febrero, siendo esta la época más fría en todo el hemisferio creando el ambiente ideal para el desarrollo de este y otros virus respiratorios, como el COVID-19.
Se cree que una nueva ola de contagios de COVID-19 surgirá durante el mes de diciembre y esto concretiza la primera temporada de Influenza y COVID-19.

Uso opcional de la mascarilla y flexibilización de actividades
Durante la pandemia del COVID-19 fue imperativo y mandatorio el distanciamiento social y uso de mascarillas como método de prevención de contagios. Hemos visto cómo gradualmente todo regresa a la nueva normalidad, las actividades multitudinarias resurgen, los viajes comienzan a resumirse y regresamos a nuestras áreas de trabajo presenciales.
Practiquemos el distanciamiento social, el uso de la mascarilla en lugares requeridos por las autoridades locales y la vacunación y refuerzos como métodos de prevención para el contagio.
Prevención de Infecciones e Innovación de Pruebas Diagnósticas
“A diferencia del año 2020, año en el cual comenzó la pandemia del COVID-19 y para el cual no había vacunas desarrolladas y las pruebas diagnósticas fueron lanzadas bajo “Autorizaciones de Emergencia por la FDA,” para esta nueva temporada simultánea si estamos preparados.”, comentó la licenciada Alba Rivera Torres.
Si usted visita a su médico porque presenta alguno de los síntomas comunes de ambos virus tales como: fiebre, dolor de cabeza, dolores musculares, estornudos y tos asegure de pedir la prueba de COVID 19/Flu A&B combinada donde recibirá los 3 resultados en una sola visita al laboratorio clínico de su comunidad o una institución de salud.
A diferencia de una prueba de Influenza o Antígeno individual, este nuevo método se realiza mediante 1 sola toma de muestra, esto se traduce en mayor comodidad al paciente, mayor flexibilidad al tecnólogo y optimización de los procesos internos de la institución de salud. La efectividad de este tipo de pruebas diagnósticas se mide por porcentajes de Sensitividad y Especificidad las cuales en los 3 resultados que provee son superiores a la mayoría de las pruebas individuales conocidas en el mercado.
Cabe resaltar que lo más importante dentro de esta nueva tecnología es que podría brindar un diagnóstico más certero y confiable y permite al profesional de la salud brindar un tratamiento individualizado para cada paciente.
Distribuidor en Puerto Rico por: (787) 745-3040 / 612-7094 | P.O Box 6824 Caguas, PR 00726 sales@rodimedi.com
Distribuidor exclusivo para las entidades de salud del Gobierno de Puerto Rico
For prescription and in vitro diagnostic use only This product has not been FDA cleared or approved but has been authorized by FDA under an Emergency Use Authorization (EUA) for use by laboratoriescertiedundertheCLIAthatmeettherequirementstoperformmoderate,high,orwaivedcomplexitytests.ThisproductisauthorizedforuseatthePointofCare(POC),i.e.,inpatient caresettingsoperatingunderaCLIACerticateofWaiver,CerticateofCompliance,orCerticateofAccreditation.



















Pruebas de In uen a Pruebas de Paternidad A Pruebas Qu micas Pruebas de opa e Pruebas de mbara o
Pruebas para el ic Pruebas de lucosa Pruebas de Co id -19 Pruebas de Colesterol Ser icio a omicilio






Actualmente el uso continuo del celular tabletas, computadoras y largas horas de trabajo en aparatos electrónicos causa que la demanda de visión este en su máximo potencial. Todo se lee y se experimenta ¿Ha notado que después de varias horas de trabajo en aparatos electrónicos su vista se cansa o se le resecan los ojos y siente la necesidad de parpadear o cerrarlos para sentir alivio? Así como le informo a mis pacientes esto no va a dejar de existir, cada día vendrá más tecnología para facilitarnos la vida, pero hay que usarlos del modo correcto.
Las condiciones refractivas comunes se corrigen con lentes oftálmicos que permiten la entrada de la luz al ojo de una manera correcta y que permita una visión clara. Primeramente, la presbiopía se define como la inhabilidad de ver objetos cercanos a unas 16 pulgadas. Podrías comenzar tu jornada laboral sintiéndote bien, pero una vez pasa el tiempo y comienzas a experimentar dolor de cabeza, alejar las cosas o usar una lupa, te recomiendo te evalúes para corregirlo con lentes progresivos que tiene tres distancias para facilitar tu trabajo. Las distancias son lejos, computadora o intermedio y lectura.

En adición, si algún niño o inclusive adulto se acerca demasiado el celular o tableta al leer es importante examinarlo ya que podría tener astigmatismo. Muchas veces se refleja de lejos con mayor dificultad en las noches, pero otras son de cerca junto con la hipermetropía, que es cuando se ve borroso de cerca y ocurre mucho en los niños o adultos mayores.
Por otro lado, la miopía puede pasar desapercibida ya que al estar en el celular, computadora o espacio cerrado constantemente no presenta quejas. Por tanto, el uso de esta tecnología y el encierro de la pandemia ha hecho que de cerca no afecte, pero cuando van al salón de clases presencialmente o a manejar en caso de un adulto no ven a distancia. Esta condición se corrige con espejuelos y lentes con tratamiento antireflectivo y con filtro de luz azul.
Para reducir el progreso de la miopía se recomienda estar por lo menos 2 horas al aire libre en ambiente abierto para evitar el progreso de la condición y limitar el uso de la tecnología con intervalos de cada dos horas. Según la organización mykidsvision.org los niños que se exponen a una edad temprana a aparatos electrónicos o tareas cercanas están mas propensos a desarrollar miopía, sumándole a esto el factor de historial familiar donde algún padre padezca la condición.
Recomiendo que actives el bloqueador de luz azul de tu celular o computadora en las noches, así podrás descansar mejor ya que la luz azul disminuye los niveles de melatonina en el cuerpo y te mantiene despierto. Al activar el filtro puedes descansar tu vista de la brillantez y dormir mejor. También trata de no usar el celular media hora antes de dormir especialmente se recomienda en los niños. Utiliza gafas de sol con protección UV durante el día, o lentes con la protección de luz azul en la exposición a aparatos electrónicos.
Finalmente, evalúa tu vista una vez al año, si ya paso más de un año haz una cita o si tus lentes están rayados pasa a evaluarte con tu Optómetra de preferencia.





 Por Enrique A. Pasarell, MD Cirujano Plástico
Por Enrique A. Pasarell, MD Cirujano Plástico
revio a 1962 el aumento de senos era hecho con implantes de PVC o los implantes de IVALON. En ese año se aprobaron los implantes de silicona en consistencia de gel. En el 1992 el “Food & Drug Administration” (FDA), puso una moratoria a los implantes de silicona gel por una duda y ausencia de estudios epidemiológicos que demostraran la no-asociación de enfermedades del tejido conectivo. Luego de salir los resultados de estos estudios por fin el implante de gel fue aprobado nuevamente en el 2006.
Irrespectivo de esto, la forma y si son de salina o gel, el aumento de senos sigue siendo una operación de alta aceptación con un grado de satisfacción altísimo en los pacientes.
Como es natural cada forma de implante y las rutas para introducirlos (en la base del seno, periferia de areola o axila) todas tienen ventajas y desventajas que el paciente debe saber mediante orientación del cirujano plástico quien debe poseer el grado de certificación por el “American Board of Plastic Surgery” (ABPS).
El procedimiento es ambulatorio y el paciente suele reintegrarse a sus actividades normales en cinco días y hasta menos. Como toda cirugía hay potencial complicaciones que afortunadamente son pocas en manos de cirujanos plásticos competentes y hecha en centros con control de calidad regulada. Estas complicaciones y su corrección deben ser cubiertas minuciosamente por el cirujano. Si el seno está caído y el pezón está más abajo que el surco inframamario o doblez del seno hay que recoger el seno con cirugía de levantamiento que puede ser al momento de aumentarlo y muchos opinamos que es mejor en dos operaciones separadas.
La verdadera desventaja del aumento de seno es la contractura del tejido de cicatriz normal que se produce alrededor y que puede endurecer el área. Normalmente un aumento de senos es útil de 10 a 15 años. En ese momento los implantes se pueden sustituir y quizás hacer otros ajustes necesarios.
La incidencia del cáncer, la habilidad de poder lactar, la sensación del pezón, la detección del cáncer de mama no suele afectarse por la presencia de los implantes.

La reducción del seno es una operación que data cerca de 100 años que comenzaron. Desde el 1960 las reducciones de seno deben preservar la sensación del pezón, la habilidad de lactancia y por supuesto reducir y levantar el seno. La operación es algo más compleja que el aumento y la cirugía tarda más. Hay heridas que se camuflan bien alrededor del pezón y a lo largo del surco inframamario. La recuperación es más lenta, usualmente de dos a tres semanas para restablecerse al trabajo o estudios y seis semanas para deportes y/o ejercicios.
De nuevo en la entrevista debe haber un tiempo adjudicado a un examen minucioso del seno, una explicación concisa de las potenciales complicaciones y no tanto poder ver un sin número de resultados espectaculares en fotografías.
Existen alternativas quirúrgicas múltiples, pero no son necesariamente mejores. Lo importante es que la paciente reciba una orientación concisa y se sienta cómoda con el cirujano plástico.










El cuidado de la piel también es salud Conoce la rutina que cubre tus necesidades básicas con CeraVe.
Las patologías más comunes de la piel pueden relacionarse con factores como resequedad, irritación, enrojecimiento y más. Muchas de estas reacciones ocurren a raíz del déficit de ceramidas, que son lípidos o grasas que naturalmente forman parte de la piel y son esenciales para mantenerla saludable. Reconociendo su importancia para reparar y reforzar la barrera cutánea, todos los productos de CeraVe contienen tres ceramidas esenciales. Además, su tecnología patentizada de Emulsión Multivesicular (MVE, por sus siglas en inglés) asegura la difusión continua de ceramidas para prolongar la hidratación por hasta 24 horas.
El cuidado de la piel no tiene que ser complicado. Muchos dermatólogos recomiendan una rutina básica con una limpiadora, una crema hidratante y protector solar. A continuación, CeraVe presenta sus recomendaciones para una rutina de cuidado adaptable según su tipo de piel y cualquier necesidad particular.


Cleanser
Esta limpiadora elimina residuos de grasa, maquillaje, protector solar y otros contaminantes de la cara. Su fórmula fue diseñada para limpiar y refrescar la piel sin alterarsubarrera.Idealparapielesnormalesasecas.
AMFacialMoisturizingLotionwithSunscreen Estacremanocomedogénicaylibresdegrasahidratael rostromientraspresentaunaprotecciónsolarSPF30.
PMFacialMoisturizingLotion
Estalociónligeraesricaeningredientescalmantespara nutriryrepararlabarreracutáneadurantelanoche.

Esta crema corporal es apta para pieles sensibles y resecasquenecesitanunahidrataciónmásprofunda.
Estos productos ayudarán a cubrir las necesidades básicas de su piel. Para atender condiciones o necesidades especiales, se recomienda visitar al dermatólogo. Conoce más sobre los productos de CeraVeatravésdeFacebookoInstagram@CeraVePR.
¿Sabías que la piel es el órgano más grande del cuerpo? Aunque el rostro suele tener más protagonismo en conversaciones sobre el cuidado de la piel, el cuerpo también es expuesto diariamente al sol, clima y contaminantes en el ambiente. En el Día Mundial de la Salud, CeraVe, marca de cuidado de la piel desarrollada con dermatólogos, refuerza la importancia del cuidado de la piel.








La patología clínica o medicina de laboratorio es una especialidad médica que se dedica al estudio de análisis de laboratorio de fluidos corporales, tales como sangre, orina, heces fecales, líquido sinovial de las articulaciones, líquido cerebroespinal, líquido pleural (alrededor de los pulmones), líquido ascítico (abdominal) y exudados del sistema respiratorio, entre otros tipos de muestras. En colaboración con los médicos primarios, especialistas y subespecialistas que refieren a sus pacientes para pruebas de laboratorios clínicos, es posible llegar a diagnósticos certeros de enfermedades, evaluar y descartar pronósticos, vigilar el comportamiento de las enfermedades a través del tiempo y monitorizar las respuestas a los tratamientos ofrecidos a los pacientes.
Los análisis de laboratorio también ayudan con la prevención de enfermedades bajo pruebas de cernimiento. En términos generales, en un laboratorio clínico se toman decisiones acertadas relacionadas al bienestar de los pacientes que en la mayoría de los casos salvan vidas. El patólogo clínico o médico especialista en medicina de laboratorio tiene la preparación para poder ser director de laboratorios clínicos de la comunidad y de hospitales. Es consultor médico para la interpretación de resultados de pruebas de laboratorio, consultor técnico dentro del laboratorio y a nivel administrativo, y cumple con los requisitos para ser director de bancos de sangre.
Los laboratorios clínicos cuentan con un nivel profesional de alta excelencia para procesar y evaluar las pruebas de laboratorio y para eso cuentan con profesionales de la salud que tienen preparación académica post-graduada, ellos son los tecnólogos médicos. El tecnólogo médico trabaja directamente las muestras utilizando equipos especializados dentro del laboratorio en todas sus especialidades: química, hematología, coagulación, bacteriología, micología, virología, serología, inmunología, genética y citología.
El tecnólogo médico es el responsable de brindar el resultado de análisis de todas las pruebas de laboratorio con precisión, exactitud y confiabilidad, desde la evaluación del buen manejo de la muestra hasta reconocer inmediatamente cualquier condición en la muestra que pueda afectar los resultados de la misma. Los tecnólogos médicos informan a los médicos de manera inmediata los resultados de laboratorio categorizados como valores críticos, que son aquellos resultados que puedan indicar una situación clínica que ponga en riesgo la vida del paciente si no es intervenido oportunamente. El tecnólogo médico también lleva a cabo un sistema de control de calidad interno para garantizar que la utilización y comportamiento de los equipos debidamente estandarizados y su despliegue de resultados sean siempre confiables. Operan, calibran y le dan el mantenimiento adecuado y necesario que requiere cada equipo de laboratorio. Velan constante y diariamente por el cumplimiento de los requisitos establecidos en las leyes y reglamentos del Departamento de Salud estatal y federal que rigen
los laboratorios clínicos. Además, velan por la seguridad dentro del laboratorio para prevenir y/o minimizar riesgos personales en la ejecución de sus deberes, incluyendo la vestimenta adecuada, uso de guantes, uso de gafas de seguridad, desinfección diaria de las áreas de trabajo, lavado constante de manos, entre otros. Igualmente, supervisan la disposición adecuada de los desperdicios biomédicos. Todos los resultados de laboratorio que se emiten son debidamente analizados y estudiados por el tecnólogo médico para asegurar la exactitud y confiabilidad de los mismos.
El trabajo del tecnólogo médico, como parte integral de la medicina de laboratorio, está lleno de retos. Es una tarea que involucra cambios constantes y adaptación inmediata a las nuevas tecnologías y metodologías automatizadas que surgen en el mercado de las ciencias de laboratorio. Ellos están comprometidos con este esfuerzo, manteniendo al día sus créditos de educación contínua que los capacitan para estos fines, incluyendo la solución y reparación de problemas con los equipos de laboratorio.
El tecnólogo médico colabora con los médicos en el manejo de sus pacientes, como proveedores de importante información científica que el médico utiliza para el diagnóstico, tratamiento, control o prevención de enfermedades, con el fin de que culmine en el mejor tratamiento y manejo para ellos. Son unos héroes, muchas veces anónimos, en el campo de la medicina de laboratorio. El personal de enfermería es otro profesional de la salud que trabaja de manera integral en el campo de la medicina de laboratorio, apoyando a los tecnólogos médicos en la toma y la recolección de las muestras para ser procesadas en el laboratorio. Conocen las características y los requisitos de cada prueba, le dan las instrucciones necesarias al paciente al momento de tomar la muestra, documentan de manera adecuada los procesos efectuados, identifican positivamente al paciente y se aseguran de obtener la cantidad de muestra necesaria con calidad, buen desempeño, y con compasión y buen trato al paciente. Una correcta toma de muestra, adecuadamente identificada, es el requisito esencial para efectuar un análisis de laboratorio de calidad. De esta manera, el personal de enfermería participa activamente en los procedimientos diagnósticos y terapéuticos del paciente.
La medicina de laboratorio es una especialidad médica que trabaja en constante colaboración con otros imprescindibles profesionales de la salud para lograr el objetivo supremo de llevar información diagnóstica con excelencia, calidad y prontitud, basada en análisis de laboratorio. Es la rama de la medicina que aplica el método científico y las tecnologías del laboratorio clínico para la toma de decisiones médicas, cuyo producto final es una atención de cuidado y esmero hacia el paciente, la esencia de la medicina.




Rodeada de familiares, amigos, pacientes y colegas, y en los acogedores espacios del hotel Condado Vandelvirt, la reconocida quiroprática y experta en salud y bienestar, Dra. Cesia Estebané, realizó el evento de lanzamineto y presentación de su libro El Doctor en Ti: 5 constructores para descubrir tu poder innato de sanar.
Entre los asistentes figuraron prominentes profesionales de la salud e influenciadores, quienes fueron recibidos por la doctora Estebané y su esposo, el Dr. José Enrique Cruz, en una hermosa terraza con vista al mar, donde disfrutaron de “Natural Mocktails” aperitivos veganos y los acordes de Tempo de Violines.
Al atardecer, los invitados pasaron al salón principal, hermosamente decorado por Luciano Designer, que inspirados en la naturaleza, crearon una atmósfera de serenidad, vida y salud, utilizando plantas naturales, flores con vida y elementos decorativos en diferentes tonalidades de verde.



Durante la presentación del libro, la autora compartió una amena tertulia con sus colaboradoras en el proyecto Anita Paniagua, de Emprende con tu Libro, y la brand manager Thaliana Méndez. Posteriormente, los asistentes disfrutaron de una cena vegana y la música del saxofonista Nathanael Pérez. “Me sentí grandemente conmovida y agradecida por el apoyo y aprecio de tanta gente. Más que el lanzamiento de mi primer libro, este evento significó una celebración de la vida misma. Este libro representa uno de mis mayores actos de amor, en el que pude manifestar mi misión y pasión de ayudar a la humanidad a sanar sus vidas y sus cuerpos de adentro hacia afuera. Es un libro hermoso, práctico, pero muy profundo, y en él comparto herramientas poderosas para que puedan ejercer su derecho de estar completamente sanos y plenos en cada área de la vida”, expresó la doctora Estebané, quien lució un vestido verde matcha, creación del diseñador Gabriel Maisonet.
Al concluir, los invitados pudieron obtener el libro El Doctor en ti, autografiado. La coordinación del evento estuvo a cargo de Thais Vázquez de Event Desing & Shop. La fotografía y video estuvo a cargo de Joshua Del Rio.






LLa Sociedad de Educación y Rehabilitación de Puerto Rico, recibe nuevamente la máxima calificación de excelencia por la prestación de servicios médicos terapéuticos que ofrece su programa de rehabilitación física a la población que convive con alguna discapacidad y/o condición adquirida en sus tres centros de: Hato Rey, Ponce y Ceiba.




CARF (por sus siglas en inglés - Comisión para la Acreditación de Instituciones de Rehabilitación Física) fundada en 1966, es una organización independiente, sin fines de lucro, que acredita a proveedores de servicios especializados de salud y sociales con el objetivo de promover la calidad, el valor y un óptimo resultado de sus programas en el área de rehabilitación.
“La máxima acreditación que CARF International otorga a SER por los próximos tres años es la validación de nuestro compromiso y misión con el pueblo al que servimos. De igual manera, certifica nuestra visión de desarrollo para que tengamos en Puerto Rico servicios únicos de excelencia, accesibles y disponibles a todo el que lo necesite”, puntualizó, Nilda Morales, presidenta y principal oficial ejecutiva de SER de P.R.
“Esta acreditación es el resultado de la extraordinaria labor y compromiso que cada uno de nuestros médicos especialistas, terapistas, clínicos, personal de administración, aportan día a día en nuestra institución a todos nuestros participantes. Reafirmamos nuestro compromiso en mantener los más altos estándares de servicios médicos en rehabilitación con la más alta tecnología y métodos comprobados de calidad mundial, siempre con respeto y empatía a nuestros participantes y sus familias”, expresó el presidente de la Junta de Directores de SER de P.R. el Lcdo. Milton L. Cruz.












Muchos estamos familiarizados con el aumento en historias y noticias de pacientes que viajan a otros países en busca de procedimientos quirúrgicos, sobre todo cosméticos, solo para retornar a sus casas con complicaciones asociadas a estas y algunas hasta la pérdida de sus vidas. Durante mi entrenamiento y como cirujano plástico en el Hospital Regional de Ponce recuerdo en muchas ocasiones tener a nuestro cuidado pacientes con diferentes complicaciones, desde infecciones, hasta pérdida de tejidos de algunos de estos pacientes, que buscando cirugías de bajo costo se desplazaban a otros países.
Hoy día, con la proliferación de las plataformas de las redes sociales, la telemedicina y otros factores han provocado que muchas personas opten por hacerse procedimientos en estos países en busca de una economía. Esto, asociado a que estos en muchas ocasiones carecen de los recursos económicos para quedarse el tiempo necesario para su recuperación, regresan antes de tiempo, poniendo en peligro sus vidas por la posibilidad en un aumento de complicaciones quirúrgicas.
Esto nos lleva a hacernos varias preguntas: ¿Cuáles son las responsabilidades y obligaciones del cirujano para con estos pacientes? ¿Cuál es la obligación financiera del paciente para algún cirujano en su país que desee poder ayudar en caso de complicaciones? ¿Es obligación del cirujano de tratar estas complicaciones? La realidad es que la contestación a todas estas preguntas, en su mayoría son negativas. Si nos dejamos llevar por los principios que nos rigen en Puerto Rico y los USA por parte de la

AMA y ACS (American Medical Association y American College of Surgeons) en que el cirujano debe asegurarse que el paciente operado reciba una continuidad en su periodo post-quirúrgico. Un cirujano ético no debe realizar una cirugía electiva en ninguna persona que no la haya examinado, diagnosticado, y sin preparación preoperatoria. El cirujano debe ser responsable del paciente operado, a menos que éste haya delegado a alguien del mismo entrenamiento cualificado para que lo haga.
El otro problema asociado a esto, ¿es quién es responsable de los gastos en que se incurra de surgir alguna complicación? Usualmente con el pago de la cirugía se incluye el cuidado post operatorio. De no ser posible porque el paciente regresa a su país antes de tiempo y sufre alguna complicación, este se siente muchas veces descontento con el resultado, y no desean pagarle a nadie más por los servicios que realice el cirujano que se haga cargo de dichas complicaciones, dejando fuera al cirujano original y total responsable de la persona, asumiendo así el nuevo cirujano la responsabilidad y los riesgos que resolver el problema conlleve. Es por eso que muchos de estos pacientes son rechazados a menos que sea una emergencia y la vida del paciente esté en peligro. Por lo tanto, es importante que, si la persona decide ir a otro país, este debe de cerciorarse de que el cirujano que elija esté debidamente entrenado y cualificado. Además, que este pueda proveer la continuidad necesaria del tratamiento y que tenga los recursos económicos, que de surgir alguna complicación se pueda pagar su estadía en lo que se resuelve la complicación que sea.
Direcci n Calle Acosta o A O Bo ega Baja 9 orario unes a iernes de A M a M Sa ados de AM a 1 MD mail landron1 la landron com
• osicionados como el primer a oratorio de e erencia de Alta complejidad en uerto ico y el Cari e uestras acilidades an sido auditadas por C IAen uerto ico y SAsin ninguna o servaci n manteniendo nuestras certi caciones de alta complejidad en todas las acilidades
• a oratorioClínico andron egaBaja
P
Direccion Ave esus i eiro San uan orario unes a iernes de AM a M S ados de AM a 1 MD el - 9mail ydepar la landron com
P
S S
Direccion orre M dica II Doctor Medical Center Carr o edro Blanco Manatí orario unes a iernes de AM a M S ados de AM a 1 M el - 9mail recepcion doctorsrefla com



Direccion Medical Art Comple Suite 9 Altona St omas S irgin Islands

